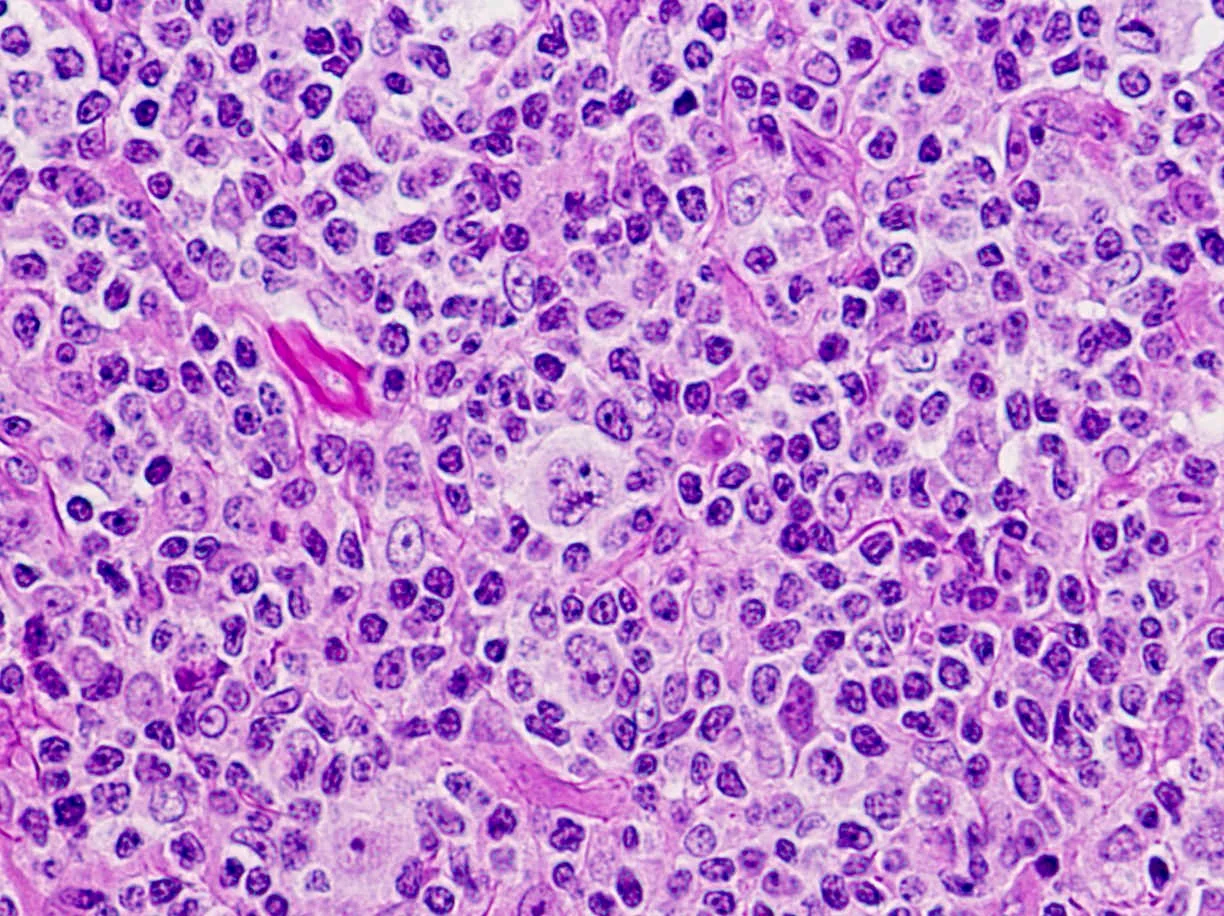
لنفوم هوچکین غالب لنفوسیت ندولار

مقدمهای بر لنفوم هوچکین
سرطان زمانی شروع میشود که سلولها شروع به رشد خارج از کنترل کنند. سلولها تقریباً در هر قسمت از بدن میتوانند به سرطان تبدیل شوند و سپس به سایر قسمتهای بدن گسترش یابند.
لنفومها (Lymphomas) سرطانهایی هستند که در گلبولهای سفید خون به نام لنفوسیتها شروع میشوند. 2 نوع اصلی لنفوم وجود دارد:
- لنفوم هوچکین (HL یا Hodgkin lymphoma)
- لنفوم غیر هوچکین (Non-Hodgkin lymphoma یا NHL)
لنفوم هوچکین و لنفوم غیر هوچکین از انواع مختلفی از سلولها میآیند. آنها رفتار، انتشار و پاسخ متفاوتی به درمان دارند، بنابراین مهم است که بدانید کدام یک را دارید.
سیستم لنفاوی (lymph system)

برای درک اینکه لنفوم هوچکین چیست، دانستن اطلاعاتی درباره سیستم لنفاوی (همچنین به عنوان سیستم لنفاتیک یا lymphatic system) کمک میکند. سیستم لنفاوی بخشی از سیستم ایمنی است که به مبارزه با عفونتها و برخی بیماریهای دیگر کمک میکند. سیستم لنفاوی همچنین به کنترل جریان مایعات در بدن کمک میکند.
سیستم لنفاوی عمدتاً از سلولهایی به نام لنفوسیتها (lymphocytes)، نوعی گلبول سفید، تشکیل شده است. 2 نوع اصلی لنفوسیت وجود دارد:
- لنفوسیتهای B (سلولهای B): سلولهای B پروتئینهایی به نام آنتی بادی میسازند تا به محافظت از بدن در برابر میکروبها (باکتریها و ویروسها) کمک کنند.
- لنفوسیتهای T (سلولهای T): انواع مختلفی از سلولهای T وجود دارد. برخی از سلولهای T میکروبها یا سلولهای غیر طبیعی بدن را از بین میبرند. سایر سلولهای T به تقویت یا کاهش فعالیت سایر سلولهای سیستم ایمنی کمک میکنند.
لنفوم هوچکین معمولا در لنفوسیتهای B شروع میشود.
شروع و گسترش لنفوم هوچکین
بافت لنفاوی در بسیاری از قسمتهای بدن شما قرار دارد، بنابراین لنفوم هوچکین میتواند تقریباً در هر جایی شروع شود.
مکانهای اصلی بافت لنفاوی عبارتند از:
- غدد لنفاوی (Lymph nodes): غدد لنفاوی مجموعه ای به اندازه لوبیا از لنفوسیتها و سایر سلولهای سیستم ایمنی هستند. آنها در سراسر بدن، از جمله داخل قفسه سینه، شکم (belly) و لگن یافت میشوند. آنها توسط سیستمی از عروق لنفاوی به یکدیگر متصل هستند.
- رگهای لنفاوی (Lymph vessels): شبکهای از لولههای کوچک (بسیار شبیه رگهای خونی) که گرههای لنفاوی را به هم متصل میکنند و سلولهای ایمنی را در مایع شفافی به نام لنف (lymph) حمل میکنند. لنف از اطراف بدن جمع آوری شده و وارد جریان خون میشود.
- طحال (Spleen): طحال عضوی است که در زیر دندههای پایینی سمت چپ شما قرار دارد. طحال بخشی از سیستم ایمنی بدن شماست. لنفوسیتها و سایر سلولهای سیستم ایمنی را میسازد. همچنین سلولهای خونی سالم را ذخیره میکند و سلولهای خونی آسیب دیده، باکتریها و ضایعات سلولی را فیلتر میکند.
- مغز استخوان (Bone marrow): مغز استخوان بافت مایع و اسفنجی داخل استخوانهای خاصی است. سلولهای خونی جدید (از جمله برخی لنفوسیتها) در آن جا ساخته میشوند.
- تیموس (Thymus): تیموس اندام کوچکی است که در پشت قسمت بالایی سینه و جلوی قلب قرار دارد. برای رشد لنفوسیت T مهم است.
- آدنوئیدها (Adenoids) و لوزهها (tonsils): اینها مجموعه ای از بافت لنفاوی در پشت گلو هستند. آنها به ساخت آنتی بادی در برابر میکروبهایی که تنفس یا بلعیده میشوند کمک میکنند.
- دستگاه گوارش (Digestive tract): معده، روده و بسیاری از اندامهای دیگر نیز دارای بافت لنفاوی هستند.
اگرچه لنفوم هوچکین میتواند تقریباً در هر جایی شروع شود، اغلب در غدد لنفاوی در قسمت فوقانی بدن آغاز میشود. شایع ترین نقاط در قفسه سینه، گردن یا زیر بازوها هستند.
لنفوم هوچکین اغلب از طریق رگهای لنفاوی از گره لنفاوی به گره لنفاوی گسترش مییابد. به ندرت، در اواخر بیماری، میتواند به جریان خون حمله کند و به سایر قسمتهای بدن مانند کبد، ریهها و یا مغز استخوان گسترش یابد.
انواع لنفوم هوچکین
انواع مختلف لنفوم هوچکین میتوانند رشد و گسترش متفاوتی داشته باشند و ممکن است به روشهای متفاوتی درمان شوند.
لنفوم هوچکین کلاسیک (Classic Hodgkin lymphoma)
لنفوم هوچکین کلاسیک (cHL) بیش از 9 مورد از 10 مورد لنفوم هوچکین در کشورهای توسعه یافته را تشکیل میدهد.
سلولهای سرطانی موجود در لنفوم هوچکین کلاسیک سلولهای رید-استرنبرگ (Reed-Sternberg cells) نامیده میشوند. این سلولها معمولا یک نوع غیر طبیعی از لنفوسیت B هستند. بزرگ شدن غدد لنفاوی در افراد مبتلا به لنفوم هوچکین کلاسیک معمولاً دارای تعداد کمی سلول Reed-Sternberg با تعداد زیادی سلول ایمنی طبیعی در اطراف آنها است. این سلولهای ایمنی دیگر باعث ایجاد بیشتر تورم در غدد لنفاوی میشوند.

لنفوم هوچکین کلاسیک دارای 4 زیرگروه است:
- لنفوم هوچکین اسکلروز ندولار یا Nodular sclerosis Hodgkin lymphoma یا NSCHL: این شایع ترین نوع لنفوم هوچکین در کشورهای توسعه یافته است. حدود 7 مورد از 10 مورد را شامل میشود. این بیماری بیشتر در نوجوانان و جوانان دیده میشود اما میتواند در افراد در هر سنی رخ دهد. تمایل دارد در غدد لنفاوی گردن یا قفسه سینه شروع شود.
- لنفوم هوچکین سلولی مختلط یا Mixed cellularity Hodgkin lymphoma یا MCCHL: این دومین نوع شایع است که در حدود 4 مورد از 10 مورد یافت میشود. بیشتر در افراد مبتلا به عفونت HIV دیده میشود. همچنین در کودکان یا افراد مسن یافت میشود. این میتواند در هر غدد لنفاوی شروع شود اما اغلب در نیمه بالایی بدن رخ میدهد.
- لنفوم هوچکین غنی از لنفوسیت (Lymphocyte-rich Hodgkin lymphoma): این نوع فرعی شایع نیست. معمولاً در نیمه بالایی بدن رخ میدهد و به ندرت در بیش از چند غدد لنفاوی یافت میشود.
- لنفوم هوچکین تخلیه شده از لنفوسیت (Lymphocyte-depleted Hodgkin lymphoma): این نوع نادر لنفوم هوچکین است. عمدتاً در افراد مسن و مبتلایان به عفونت HIV دیده میشود. نسبت به سایر انواع لنفوم هوچکین تهاجمی تر است و احتمالاً در زمان پیدا شدن پیشرفته خواهد بود.
اغلب در غدد لنفاوی شکم (belly) و همچنین در طحال، کبد و مغز استخوان وجود دارد.
لنفوم هوچکین غالب لنفوسیت ندولار (Nodular lymphocyte-predominant Hodgkin lymphoma)
لنفوم هوچکین غالب با لنفوسیت ندولار (NLPHL) حدود 5 درصد موارد را تشکیل میدهد. سلولهای سرطانی موجود در NLPHL سلولهای بزرگی به نام سلولهای پاپ کورن (popcorn cells) هستند (چون شبیه پاپ کورن هستند) که انواعی از سلولهای رید-استرنبرگ هستند. همچنین ممکن است این سلولها را با نام سلولهای لنفوسیتی و هیستیوسیتی (L&H) نیز بشنوید.
NLPHL معمولاً در غدد لنفاوی گردن و زیر بازو شروع میشود. این میتواند در افراد در هر سنی رخ دهد و در مردان شایع تر از زنان است. این نوع لنفوم هوچکین به کندی رشد میکند و متفاوت از انواع کلاسیک درمان میشود.
آمار کلیدی برای لنفوم هوچکین
برآوردهای انجمن سرطان آمریکا برای لنفوم هوچکین در ایالات متحده برای سال 2023 عبارتند از:
- حدود 8830 مورد جدید (4850 مورد در مرد و 3980 مورد در زن)
- حدود 900 مرگ (540 مرد و 360 زن)
هم کودکان و هم بزرگسالان میتوانند به لنفوم هوچکین مبتلا شوند اما این بیماری در اوایل بزرگسالی (به ویژه در دهه 20 سالگی) شایع است. خطر ابتلا به لنفوم هوچکین در اواخر بزرگسالی (پس از 55 سالگی) دوباره افزایش مییابد. به طور کلی، میانگین سنی افراد در هنگام تشخیص 39 سال است.
لنفوم هوچکین در کودکان کمتر از 5 سال نادر است اما این شایع ترین سرطانی است که در نوجوانان 15 تا 19 ساله تشخیص داده میشود.
میزان بروز لنفوم هوچکین از اواسط دهه 2000 حدود 1 درصد در سال کاهش یافته است. میزان بقا در چند دهه گذشته بیشتر به دلیل پیشرفت در درمان بهبود یافته است. نرخ بقای نسبی 5 ساله برای همه بیماران مبتلا به لنفوم هوچکین در حال حاضر حدود 89 درصد است. عوامل خاصی مانند مرحله (وسعت) لنفوم هوچکین و سن فرد بر این میزان تأثیر میگذارد.
علائم و نشانههای لنفوم هوچکین
شما یا فرزندتان میتوانید (HL) داشته باشید و احساس خوبی داشته باشید اما لنفوم هوچکین اغلب باعث علائم یا تغییراتی میشود که باید توسط پزشک بررسی شود.
توده (های) زیر پوست
شایع ترین علامت لنفوم هوچکین یک توده در گردن، زیر بازو یا در کشاله ران است که یک غده لنفاوی بزرگ شده است. معمولاً درد ندارد اما ممکن است بعد از نوشیدن الکل دردناک شود. این توده ممکن است با گذشت زمان بزرگتر شود یا ممکن است تودههای جدیدی در نزدیکی آن یا حتی در سایر قسمتهای بدن ظاهر شوند.
با این حال، لنفوم هوچکین شایع ترین علت تورم غدد لنفاوی نیست. بیشتر غدد لنفاوی بزرگ شده، به ویژه در کودکان، در اثر عفونت ایجاد میشوند. گرههای لنفاوی که به دلیل عفونت رشد میکنند، گرههای واکنشی (reactive nodes) یا هیپرپلاستیک (hyperplastic nodes) نامیده میشوند. اینها اغلب وقتی لمس میشوند صدمه میبینند. اگر علت عفونت باشد، بعد از از بین رفتن عفونت، گره باید به اندازه طبیعی خود برگردد.
سایر سرطانها نیز میتوانند باعث تورم غدد لنفاوی شوند. اگر غدد لنفاوی شما بزرگ شده است، به خصوص اگر عفونت جدیدی نداشته اید، بهتر است به پزشک مراجعه کنید تا در صورت نیاز بتوان علت را پیدا کرده و آن را درمان کرد.
علائم B
برخی از افراد مبتلا به لنفوم هوچکین علائم B را دارند:
- تب (که میتواند طی چند هفته بوجود بیاید و از بین برود) بدون عفونت
- تعریق شبانه خیس کننده
- کاهش وزن بدون تلاش (حداقل 10 درصد وزن بدن شما در طی 6 ماه)
این علائم بخش مهمی از مرحله بندی لنفوم هوچکین و تعیین چشم انداز فرد است.
علائم عمومی (غیر اختصاصی)
سایر علائم احتمالی لنفوم هوچکین عبارتند از:
- خارش پوست
- احساس خستگی (fatigue)
- از دست دادن اشتها
گاهی اوقات تنها علامت ممکن است احساس خستگی دائمی باشد.
سرفه، مشکل در تنفس، درد قفسه سینه
اگر لنفوم هوچکین غدد لنفاوی داخل قفسه سینه شما را تحت تاثیر قرار دهد، تورم این گرهها ممکن است بر روی نای (trachea) فشار بیاورد و باعث سرفه یا حتی مشکلات تنفسی شود، به خصوص در حالت دراز کشیدن. برخی افراد ممکن است پشت استخوان سینه درد داشته باشند.
اگر علائم دارید:
داشتن یک یا چند مورد از علائم بالا به این معنی نیست که شما قطعا لنفوم هوچکین دارید. در واقع، بسیاری از این علائم به احتمال زیاد ناشی از مشکلات دیگری مانند عفونت هستند. با این حال، اگر شما یا فرزندتان هر یک از این علائم را دارید، آنها را توسط پزشک معاینه کنید تا بتوان علت را پیدا کرده و در صورت نیاز آن را درمان کرد.
چه چیزی باعث لنفوم هوچکین میشود؟
برخی از محققان فکر میکنند که عفونت با ویروس اپشتین بار (Epstein-Barr virus) گاهی اوقات باعث تغییرات DNA در لنفوسیتهای B میشود. در برخی موارد، این منجر به رشد سلولهای Reed-Sternberg میشود که سلولهای سرطانی در لنفوم هوچکین هستند.
DNA ماده شیمیایی موجود در سلولهای ما است که ژنهای ما را میسازد که نحوه عملکرد سلولهای ما را کنترل میکند. ما شبیه والدین خود هستیم زیرا آنها منبع DNA ما هستند اما DNA چیزی بیش از ظاهر ما را تحت تأثیر قرار میدهد.
برخی از ژنها زمان رشد، تقسیم به سلولهای جدید و مرگ سلولها را کنترل میکنند:
- ژنهایی که به رشد، تقسیم و زنده ماندن سلولها کمک میکنند، انکوژن (oncogenes) نامیده میشوند.
- ژنهایی که تقسیم سلولی را کند میکنند یا باعث مرگ سلولها در زمان مناسب میشوند، ژنهای سرکوب کننده تومور (tumor suppressor genes) نامیده میشوند.
سرطانها میتوانند ناشی از تغییرات DNA باشند که انکوژنها را فعال میکند یا ژنهای سرکوب کننده تومور را خاموش میکند.
دانشمندان تغییرات ژنی بسیاری را در سلولهای رید استرنبرگ یافته اند که به رشد و تقسیم سلولها کمک میکند یا باعث میشوند بیشتر از آن چه باید عمر کنند. سلولهای رید استرنبرگ نیز موادی به نام سایتوکاین (cytokines) میسازند که بسیاری از سلولهای دیگر را به غدد لنفاوی جذب کرده و باعث تورم (بزرگ شدن) آن میشود. به نوبه خود، این سلولهای غیر سرطانی موادی را آزاد میکنند که به رشد سلولهای رید-استرنبرگ کمک میکند.
علیرغم پیشرفت در شناخت نحوه عملکرد سلولهای سرطانی، دانشمندان هنوز نمیدانند چه چیزی این فرآیندها را آغاز میکند. واکنش غیر طبیعی به عفونت با EBV یا سایر عفونتها ممکن است در برخی موارد محرک باشد اما تحقیقات بیشتری برای درک علت ایجاد لنفوم هوچکین مورد نیاز است.
عوامل خطرزا لنفوم هوچکین
عامل خطرزا هر چیزی است که بر شانس ابتلا به بیماری مانند سرطان تأثیر میگذارد. سرطانهای مختلف عوامل خطرزا متفاوتی دارند. برخی از عوامل خطرزا سرطان مانند سیگار کشیدن یا اضافه وزن را میتوان تغییر داد. موارد دیگر، مانند سن یا سابقه خانوادگی فرد، قابل تغییر نیستند.
چند عامل خطرزا احتمال ابتلای فرد به لنفوم هوچکین (HL) را افزایش میدهند اما همیشه مشخص نیست که چرا این عوامل خطر ابتلا را زیاد می کنند. داشتن یک عامل خطرزا یا حتی تعداد زیادی از آنها، به این معنی نیست که شما قطعاً به این بیماری مبتلا خواهید شد.
عفونت یا مونونوکلئوز ویروس اپشتین بار
ویروس اپشتین بار (EBV) باعث مونونوکلئوز عفونی (اغلب مونو یا infectious mononucleosis) میشود. افرادی که مونو داشته اند در معرض خطر ابتلا به لنفوم هوچکین هستند اما با وجود اینکه این خطر بیشتر از افرادی است که مونو نداشته اند اما هنوز بسیار اندک است (حدود 1 در 1000).

نقش دقیق EBV در توسعه لنفوم هوچکین مشخص نیست. بسیاری از افراد مبتلا به EBV هستند اما تعداد کمی از افراد به HL مبتلا میشوند. بخشهایی از ویروس در سلولهای Reed-Sternberg در حدود ۱ نفر از ۴ نفر مبتلا به لنفوم هوچکین کلاسیک در ایالات متحده یافت میشود اما اکثر افراد مبتلا به HL هیچ نشانه ای از EBV در سلولهای سرطانی خود ندارند.
سن
افراد مبتلا به لنفوم هوچکین در هر سنی قابل تشخیص هستند اما این بیماری در اوایل بزرگسالی (به ویژه در دهه 20 سالگی) و در اواخر بزرگسالی (پس از 55 سالگی) شایع است.
جنسیت
لنفوم هوچکین در مردان کمی بیشتر از زنان رخ میدهد.
سابقه خانوادگی
برادران و خواهران افراد جوان مبتلا به این بیماری در معرض خطر بیشتری برای HL هستند. این خطر برای دوقلوهای همسان یک فرد مبتلا به HL بسیار زیاد است اما پیوند خانوادگی هنوز غیر معمول است – اکثر افراد مبتلا به لنفوم هوچکین سابقه خانوادگی آن را ندارند.
مشخص نیست که چرا سابقه خانوادگی ممکن است خطر را افزایش دهد. ممکن است به این دلیل باشد که اعضای خانواده در دوران کودکی در معرض عفونتهای خاص (مانند ویروس اپشتین بار) قرار داشته اند زیرا آنها تغییرات ژنی ارثی را به اشتراک میگذارند که احتمال ابتلای آنها به HL یا ترکیبی از این عوامل را افزایش میدهد.
سیستم ایمنی ضعیف شده
خطر لنفوم هوچکین در افراد آلوده به HIV – ویروسی که باعث ایدز میشود – افزایش مییابد.
افرادی که پس از پیوند عضو از داروهایی برای سرکوب سیستم ایمنی استفاده میکنند و افراد مبتلا به بیماریهای خودایمنی نیز در معرض خطر ابتلا به HL از حد طبیعی هستند.
آیا میتوان از لنفوم هوچکین پیشگیری کرد؟
تعداد کمی از عوامل خطرزا شناخته شده برای لنفوم هوچکین (HL) را میتوان تغییر داد، بنابراین در حال حاضر امکان پیشگیری از اکثر موارد این بیماری وجود ندارد.
عفونت با HIV – ویروسی که باعث ایدز میشود – خطر را افزایش میدهد، بنابراین یکی از راههای محدود کردن خطر، اجتناب از عوامل خطرزا شناختهشده برای HIV است، مانند مصرف مواد مخدر داخل وریدی (IV) یا رابطه جنسی محافظت نشده با بسیاری از شرکا.
یکی دیگر از عوامل خطرزا برای لنفوم هوچکین عفونت با ویروس اپشتین بار (عامل مونونوکلئوز عفونی یا مونو) است اما هیچ راه شناخته شده ای برای جلوگیری از این عفونت وجود ندارد.
آیا میتوان لنفوم هوچکین را زود تشخیص داد؟
آزمایشات یا معاینات غربالگری برای بررسی بیماری در افرادی که هیچ علامتی ندارند، استفاده میشود. در حال حاضر، هیچ آزمایش غربالگری به طور گسترده ای برای لنفوم هوچکین (HL) وجود ندارد زیرا هیچ آزمایش غربالگری نشان داده نشده است که خطر مرگ ناشی از این سرطان را کاهش دهد. با این حال، در برخی موارد HL را میتوان در مراحل اولیه یافت.
بهترین راه برای یافتن زودهنگام لنفوم هوچکین این است که مراقب علائم احتمالی باشید. شایع ترین علامت بزرگ شدن یا تورم یک یا چند غدد لنفاوی است که باعث ایجاد توده یا برآمدگی در زیر پوست میشود که معمولاً درد ندارد. اغلب در کنار گردن، زیر بغل یا کشاله ران است. بیشتر اوقات این عارضه ناشی از چیزی مانند عفونت است، نه HL اما مهم است که چنین تودههایی توسط پزشک بررسی شود.
معاینات پزشکی دقیق و منظم ممکن است برای افرادی که دارای عوامل خطرزا شناخته شده برای HL هستند، مانند سابقه خانوادگی قوی، مفید باشد. این افراد اغلب HL دریافت نمیکنند اما آنها (و پزشکانشان) باید در مورد علائم و نشانههای احتمالی که ممکن است داشته باشند، بدانند.
آزمایشات لنفوم هوچکین
اکثر افراد مبتلا به لنفوم هوچکین (HL) به پزشک خود مراجعه میکنند زیرا علائم خاصی دارند یا به این دلیل که احساس خوبی ندارند برای معاینه مراجعه میکنند.
اگر فردی نشانه یا علائمی داشته باشد که نشان دهنده لنفوم هوچکین باشد، معاینات و آزمایشاتی انجام میشود تا مطمئن شود و در صورت وجود، نوع دقیق آن مشخص شود.
سابقه پزشکی و معاینه فیزیکی
پزشک میخواهد یک تاریخچه پزشکی کامل را از شما بگیرد.
از شما در مورد علائم، عوامل خطرزا احتمالی، سابقه خانوادگی و سایر شرایط پزشکی سوال میشود.
در مرحله بعد، پزشک شما (یا فرزندتان) را معاینه میکند و به غدد لنفاوی و سایر قسمتهای بدن که ممکن است تحت تأثیر قرار گیرند، از جمله طحال و کبد، توجه زیادی داشته باشد. از آن جایی که عفونتها شایع ترین علت بزرگ شدن غدد لنفاوی هستند، به ویژه در کودکان، پزشک به دنبال عفونت در قسمتی از بدن در نزدیکی گرههای لنفاوی متورم شده است.
پزشک همچنین ممکن است آزمایش خون را برای بررسی علائم عفونت یا سایر مشکلات تجویز کند. اگر پزشک مشکوک باشد که HL ممکن است مشکل اصلی باشد، بیوپسی از یک غدد لنفاوی متورم ممکن است توصیه شود.
بیوپسیها (Biopsies)
از آن جایی که غدد لنفاوی متورم به احتمال زیاد ناشی از چیزی غیر از لنفوم هوچکین است، مانند عفونت، پزشکان اغلب چند هفته صبر میکنند تا ببینند که آیا با از بین رفتن عفونت، آنها به خودی خود کوچک میشوند یا خیر. ممکن است به شما آنتی بیوتیک داده شود تا ببینید آیا باعث کوچک شدن گرهها میشود یا خیر.

اگر گرهها کوچک نشوند یا به رشد خود ادامه دهند، یک گره لنفاوی (یا یک قطعه کوچک از یک گره) خارج میشود تا در آزمایشگاه بررسی شود. این روش که بیوپسی نام دارد، تنها راه برای اطمینان از تشخیص است. اگر HL باشد، بیوپسی نیز میتواند نوع آن را نشان دهد.
انواع بیوپسی
بیوپسی انواع مختلفی دارد. پزشکان بر اساس شرایط، بهترین را برای انجام انتخاب میکنند.
بیوپسی اکسیزیونال (Excisional biopsy) یا برشی (incisional biopsy): این نوع بیوپسی ترجیحی و رایج برای بزرگ شدن غدد لنفاوی است. پزشک برای برداشتن غده لنفاوی پوست را برش میدهد.
- اگر کل غدد لنفاوی برداشته شود، بیوپسی اکسیزیونال است.
- اگر قسمت کوچکی از تومور یا گره بزرگتر برداشته شود، بیوپسی برشی است.
اگر گره درست زیر پوست باشد، بیوپسی نسبتاً ساده است و گاهی اوقات میتوان با داروهای بی حس کننده (به نام بی حسی موضعی) آن را انجام داد اما اگر گره داخل قفسه سینه یا شکم (belly) باشد، داروی آرام بخش به شما داده میشود یا تحت بیهوشی عمومی (که در آن از داروها برای خواب عمیق استفاده میشود) قرار میگیرید. این نوع بیوپسی تقریباً همیشه بافت کافی برای تشخیص HL و تشخیص نوع دقیق را فراهم میکند.
- بیوپسی سوزنی (Needle biopsy): بیوپسی سوزنی نسبت به بیوپسیهای برشی یا اکسیزیونال تهاجم کمتری دارد زیرا هیچ برشی در پوست وجود ندارد اما اشکال این است که ممکن است بافت کافی برای تشخیص HL (یا پیدا کردن نوع آن) نداشته باشد. 2 نوع اصلی بیوپسی سوزنی وجود دارد:
- بیوپسی با سوزن ظریف (fine needle aspiration یا FNA) از یک سوزن بسیار نازک و توخالی متصل به سرنگ استفاده میکند تا مقدار کمی مایع و تکههای ریز بافت را خارج کند.

بیوپسی با سوزن مرکزی (core needle biopsy) از یک سوزن بزرگتر برای برداشتن یک قطعه کمی بزرگتر از بافت استفاده میکند.
برای بیوپسی یک گره بزرگ شده درست زیر پوست، پزشک میتواند سوزن را در حالی که گره را احساس میکند، نشانه بگیرد. اگر یک گره یا تومور در اعماق بدن باشد، میتوان از سی تی اسکن یا اولتراسوند برای هدایت سوزن استفاده کرد.
اکثر پزشکان از بیوپسی سوزنی (به ویژه بیوپسی FNA) برای تشخیص HL استفاده نمیکنند اما اگر پزشک مشکوک باشد که تورم غدد لنفاوی ناشی از عفونت یا گسترش سرطان از اندام دیگری (مانند سینه، ریه یا تیروئید) است، بیوپسی سوزنی ممکن است اولین نوع بیوپسی باشد. حتی پس از انجام بیوپسی سوزنی ممکن است همچنان برای تشخیص HL نیاز به بیوپسی اکسیزیونال باشد.
اگر HL قبلاً تشخیص داده شده باشد، گاهی اوقات از بیوپسی سوزنی برای بررسی تغییرات (مانند گرههای متورم) در سایر قسمتهای بدن که ممکن است ناشی از گسترش یا بازگشت لنفوم پس از درمان باشد، استفاده میشود.
آسپیراسیون مغز استخوان (Bone marrow aspiration) و بیوپسی: این آزمایشها برای تشخیص HL استفاده نمیشوند اما ممکن است پس از تشخیص انجام شوند تا ببینند آیا لنفوم در مغز استخوان است یا خیر. آسپیراسیون مغز استخوان و بیوپسی معمولاً همزمان انجام میشود. نمونهها از پشت استخوان لگن (hip) گرفته میشوند اما گاهی اوقات ممکن است از استخوانهای دیگر نیز گرفته شوند.

در آسپیراسیون مغز استخوان، روی یک میز (به پهلو یا روی شکم) دراز میکشید. پس از تمیز کردن پوست روی لگن، پزشک با تزریق یک بی حس کننده موضعی (داروی بی حس کننده) پوست و سطح استخوان را بی حس میکند. این ممکن است باعث ایجاد یک احساس درد یا سوزش مختصر شود. سپس یک سوزن نازک و توخالی به داخل استخوان فشار داده میشود و از یک سرنگ برای مکیدن مقدار کمی از مغز استخوان مایع استفاده میشود. حتی با استفاده از داروی بیهوشی، اکثر بیماران هنگام بیرون کشیدن مغز استخوان درد مختصری دارند.
بیوپسی مغز استخوان معمولاً درست بعد از آسپیراسیون انجام میشود. یک تکه یا هسته کوچک استخوان و مغز با یک سوزن کمی بزرگتر که به داخل استخوان فشار داده میشود، برداشته میشود. بیوپسی ممکن است کمی درد نیز ایجاد کند.
به اکثر کودکانی که آسپیراسیون مغز استخوان و بیوپسی انجام میدهند، یا دارو داده میشود تا خواب آلود شوند یا تحت بیهوشی عمومی قرار میگیرند تا در حین انجام آن بخوابند.
تستهای آزمایشگاهی نمونههای بیوپسی
تمام نمونههای بیوپسی توسط یک پاتولوژیست (پزشکی که مخصوصاً برای تشخیص سلولهای سرطانی آموزش دیده است) زیر میکروسکوپ بررسی میشود که به دنبال سلولهای لنفوم هوچکین (به نام سلولهای رید-استرنبرگ) میگردد. گاهی اوقات اولین بیوپسی پاسخ روشنی نمیدهد و بیوپسیهای بیشتری مورد نیاز است.
نگاه کردن به نمونههای بافت زیر میکروسکوپ اغلب برای تشخیص HL (و نوع آن) کافی است اما گاهی اوقات به تستهای آزمایشگاهی بیشتری نیاز است.
ایمونوهیستوشیمی (Immunohistochemistry): این تست آزمایشگاهی پروتئینهای خاصی مانند CD15 و CD30 را روی سلولها جستجو میکند. اینها در سطح سلولهای رید-استرنبرگ در لنفوم هوچکین کلاسیک (cHL) یافت میشوند. آزمایشهای سایر پروتئینها ممکن است به لنفوم هوچکین (NLPHL) با لنفوسیت ندولر، به لنفوم غیر هوچکین (به جای لنفوم هوچکین) یا شاید به بیماریهای دیگر اشاره کند.
تستهای تصویر برداری
آزمایشهای تصویر برداری از اشعه ایکس، امواج صوتی، میدانهای مغناطیسی یا ذرات رادیواکتیو برای ایجاد تصاویری از داخل بدن استفاده میکنند. تستهای تصویر برداری را میتوان به روشهای مختلفی استفاده کرد، مانند:
- برای جستجوی علل احتمالی علائم خاص، مانند بزرگ شدن غدد لنفاوی در قفسه سینه
- کمک به تعیین مرحله (وسعت) لنفوم هوچکین
- برای کمک به نشان دادن اینکه آیا درمان موثر است یا خیر.
- برای جستجوی علائم احتمالی سرطان پس از درمان
اینها آزمایشات تصویر برداری هستند که بیشتر مورد استفاده قرار میگیرند:
اشعه ایکس قفسه سینه (Chest x-ray)
HL اغلب غدد لنفاوی قفسه سینه را بزرگ میکند. این اغلب در عکس قفسه سینه قابل مشاهده است.
اسکن توموگرافی کامپیوتری (Computed tomography یا CT)

سی تی اسکن بسیاری از پرتوهای اشعه ایکس را ترکیب میکند تا تصاویر مقطعی دقیقی از بدن شما ایجاد کند. این اسکن میتواند به بزرگ شدن غدد لنفاوی یا اندامهای بدن شما کمک کند. سی تی اسکن برای جستجوی HL در گردن، قفسه سینه، شکم (belly) و لگن مفید است.
بیوپسی سوزنی با هدایت CT (CT-guided needle biopsy): از سی تی اسکن نیز میتوان برای هدایت سوزن بیوپسی به ناحیه مشکوک استفاده کرد. برای این روش، فرد روی میز سی تی اسکن دراز میکشد در حالی که پزشک سوزن بیوپسی را از طریق پوست و به سمت ناحیه حرکت میدهد. سی تی اسکن تا زمانی که سوزن در جای مناسب قرار گیرد تکرار میشود. سپس نمونه بیوپسی برداشته شده و به آزمایشگاه فرستاده میشود تا زیر میکروسکوپ بررسی شود.
تصویر برداری رزونانس مغناطیسی (MRI یا Magnetic resonance imaging)

مانند سی تی اسکن، MRI تصاویر دقیقی از بافتهای نرم بدن نشان میدهد اما MRI از امواج رادیویی و آهنرباهای قوی به جای اشعه ایکس استفاده میکند. این آزمایش به ندرت در HL استفاده میشود اما اگر پزشک نگران گسترش به نخاع یا مغز باشد، MRI برای بررسی این نواحی بسیار مفید است.
اسکن توموگرافی گسیل پوزیترون (Positron emission tomography یا PET)
برای اسکن PET، شکل کمی رادیواکتیو قندی وارد خون شما میشود. با گذشت زمان، در سلولهای بسیار فعال مانند سلولهای سرطانی جمع میشود. سپس از یک دوربین مخصوص برای ایجاد تصویری از قسمتهایی از بدن که رادیواکتیویته در آن جا جمع شده است، استفاده میشود. تصویر مانند سی تی اسکن یا ام آر آی دقیق نیست اما میتواند اطلاعات مفیدی در مورد کل بدن شما ارائه دهد.
اسکن PET میتواند به دلایل زیادی در افراد مبتلا به HL استفاده شود:
- آنها میتوانند نشان دهند که آیا غدد لنفاوی بزرگ شده حاوی HL است یا خیر.
- آنها میتوانند به یافتن نقاط کوچکی در بدن کمک کنند که ممکن است لنفوم باشد، حتی اگر ناحیه در سی تی اسکن طبیعی به نظر برسد.
- آنها میتوانند به تشخیص این که آیا لنفوم به درمان پاسخ میدهد یا خیر کمک کنند. برخی از پزشکان پس از چند دوره شیمی درمانی، اسکن PET را تکرار میکنند. اگر کار کند، غدد لنفاوی دیگر قند رادیواکتیو را نمیگیرند.
- آنها را میتوان بعد از درمان برای کمک به تصمیم گیری در مورد اینکه آیا یک غده لنفاوی بزرگ شده هنوز سرطان دارد یا اینکه فقط بافت اسکار است، استفاده کرد.
اسکن PET/CT: برخی از ماشینها میتوانند همزمان PET و هم سی تی اسکن را انجام دهند. این به پزشک اجازه میدهد مناطق پرتوزای بالاتر در اسکن PET را با تصاویر دقیقتر از سی تی اسکن مقایسه کند. اسکن PET/CT اغلب بهتر از سی تی اسکن به تنهایی میتواند به شناسایی نواحی لنفوم کمک کند.
اسکن استخوان (Bone scan)

اسکن استخوان معمولاً انجام نمیشود مگر اینکه فرد درد استخوانی داشته باشد یا نتایج تستهای آزمایشگاهی نشان دهد که لنفوم ممکن است به استخوانها رسیده باشد.
برای این آزمایش، یک ماده رادیواکتیو به داخل سیاهرگ تزریق میشود. به نواحی آسیب دیده استخوان میرود و یک دوربین مخصوص میتواند رادیواکتیویته را تشخیص دهد. HL گاهی اوقات باعث آسیب استخوان میشود که ممکن است در اسکن استخوان مشخص شود اما اسکن استخوان نمیتواند تفاوت بین سرطانها و مشکلات غیر سرطانی را نشان دهد، بنابراین ممکن است آزمایشهای بیشتری مورد نیاز باشد.
تستهای دیگر
آزمایشات خون
آزمایشهای خون برای تشخیص HL استفاده نمیشوند اما میتوانند به پزشک شما کمک کنند تا بفهمد بیماری چقدر پیشرفته است و چقدر ممکن است تا برخی درمانها را تحمل کنید.
شمارش کامل خون (complete blood count یا CBC) آزمایشی است که سطح سلولهای مختلف خون را اندازه گیری میکند. افراد مبتلا به HL گاهی اوقات ممکن است شمارش خون غیر طبیعی داشته باشند. به عنوان مثال، اگر لنفوم به مغز استخوان (جایی که سلولهای خونی جدید ساخته میشود) حمله کند، ممکن است فرد مبتلا به کم خونی باشد (گلبولهای قرمز کافی نیست). افزایش تعداد گلبولهای سفید خون یکی دیگر از علائم احتمالی HL است، اگرچه ممکن است ناشی از عفونت نیز باشد.
آزمایشی به نام نرخ رسوب گلبولهای قرمز (ESR یا erythrocyte sedimentation rate) میتواند به اندازه گیری میزان التهاب در بدن کمک کند. ممکن است در برخی از افراد مبتلا به HL افزایش یابد.
همچنین ممکن است آزمایش خون برای بررسی عملکرد کبد و کلیه و جستجوی علائمی مبنی بر رسیدن سرطان به استخوانها انجام شود. برخی از زنان ممکن است آزمایش بارداری انجام دهند.
پزشک ممکن است آزمایشهای خون دیگری را نیز برای بررسی علائم عفونتهای خاص پیشنهاد کند:
- آزمایش اچ آی وی (HIV test): در صورت داشتن علائم غیر طبیعی که ممکن است مربوط به عفونت HIV باشد، این آزمایش ممکن است انجام شود.

- آزمایش ویروس هپاتیت B و C: در صورت ابتلا به این عفونتها، برخی از داروهای شیمی درمانی میتوانند مشکلاتی ایجاد کنند.
تستهای عملکرد قلب و ریه
اگر قرار باشد از داروهای شیمی درمانی خاصی استفاده شود که میتواند بر قلب یا ریهها تأثیر بگذارد، این آزمایشها انجام میشود.
- برای بررسی عملکرد قلب میتوان از اکوکاردیوگرام (سونوگرافی قلب) یا اسکن MUGA استفاده کرد.
- تستهای عملکرد ریه (Lung (pulmonary) function tests یا PFTs) میتواند برای مشاهده میزان عملکرد ریهها استفاده شود.
مراحل لنفوم هوچکین
پس از اینکه فردی مبتلا به لنفوم هوچکین (HL) تشخیص داده شد، پزشکان سعی میکنند بفهمند که آیا این لنفوم گسترش یافته است یا خیر و اگر چنین است، این گسترش تا کجاست. این فرآیند مرحله بندی (staging) نامیده میشود. مرحله سرطان، میزان سرطان در بدن را توصیف میکند. این به تعیین اینکه سرطان چقدر جدی است و بهترین روش درمان آن کمک میکند. پزشکان همچنین هنگام صحبت در مورد آمار بقا از مرحله سرطان استفاده میکنند.
HL به طور کلی در غدد لنفاوی شروع میشود. اگر گسترش یابد، معمولاً به مجموعه دیگری از غدد لنفاوی مجاور میرسد. میتواند به اندامهای مجاور نیز حمله کند (رشد کند). به ندرت، HL در عضوی غیر از غدد لنفاوی مانند ریه شروع میشود.
مرحله بر أساس موارد زیر تعیین میشود:
- سابقه پزشکی شما
- اگر علائم خاصی دارید (به نام علائم B)
- معاینه فیزیکی
- بیوپسی
- آزمایشات تصویر برداری که معمولاً شامل رادیوگرافی قفسه سینه، سی تی اسکن قفسه سینه، شکم یا لگن و اسکن PET است.
- آسپیراسیون مغز استخوان و بیوپسی (گاهی اوقات اما همیشه انجام نمیشود.)
این معاینات، آزمایشها و بیوپسیها در مبحث تستهای مربوط به لنفوم هوچکین مورد بحث قرار گرفته اند.
به طور کلی نتایج آزمایشهای تصویر برداری مانند PET و سی تی اسکن در تعیین مرحله لنفوم بیشترین اهمیت را دارند.
طبقه بندی لوگانو (Lugano classification)
سیستم مرحله بندی راهی برای تیم مراقبت از سرطان است تا میزان گسترش سرطان را جمع بندی کند. سیستم مرحله بندی مورد استفاده برای لنفوم هوچکین طبقه بندی لوگانو است که بر اساس سیستم قدیمیتر Ann Arbor است. دارای 4 مرحله با برچسب I، II، III و IV است.
برای مرحله محدود (I یا II) HL که اندامی خارج از سیستم لنفاوی را تحت تاثیر قرار میدهد، حرف E به مرحله اضافه میشود (به عنوان مثال، مرحله IE یا IIE).
مرحله I: هر یک از موارد زیر به این معنی است که HL مرحله I است:
- HL تنها در 1 ناحیه غدد لنفاوی یا اندام لنفاوی مانند تیموس (I) یافت میشود.
- سرطان فقط در 1 قسمت از 1 اندام خارج از سیستم لنفاوی (IE) یافت میشود.
مرحله II: هر یک از موارد زیر به این معنی است که HL مرحله دوم است:
- HL در 2 یا چند ناحیه غدد لنفاوی در همان سمت (بالا یا پایین) دیافراگم که عضله نازک زیر ریهها است که قفسه سینه و شکم را جدا میکند، یافت میشود (II).
- سرطان به صورت موضعی از یک ناحیه غدد لنفاوی به اندام مجاور (IIE) گسترش مییابد.
مرحله III: هر یک از موارد زیر به این معنی است که HL مرحله III است:
- HL در نواحی غدد لنفاوی در دو طرف (بالا و پایین) دیافراگم (III) یافت میشود.
- HL در غدد لنفاوی بالای دیافراگم و در طحال است.
مرحلهIV : HL به طور گسترده در حداقل یک عضو خارج از سیستم لنفاوی مانند کبد، مغز استخوان یا ریهها گسترش یافته است.
اصطلاحهای دیگری نیز ممکن است برای توصیف مرحله لنفوم هوچکین استفاده شوند:
بیماری حجیم (Bulky disease)
این اصطلاح برای توصیف تومورهایی در قفسه سینه با عرض حداقل یک سوم به اندازه قفسه سینه یا تومورهایی در سایر نواحی که حداقل 10 سانتی متر (حدود 4 اینچ) عرض دارند، استفاده میشود. معمولاً با اضافه کردن حرف X به مرحله برچسب گذاری میشود. این امر به ویژه برای لنفومهای مرحله دوم مهم است زیرا بیماری حجیم ممکن است به درمان شدیدتری نیاز داشته باشد.
A در مقابل B
همچنین ممکن است به هر مرحله یک حرف (A یا B) اختصاص داده شود. B اضافه میشود (مرحله IIIB، برای مثال) اگر فردی هر یک از این علائم B را داشته باشد:
- کاهش بیش از 10 درصد وزن بدن در 6 ماه گذشته (بدون رژیم غذایی)
- تب بدون دلیل حداقل ۴/۱۰۰ درجه فارنهایت (38 درجه سانتیگراد)
- تعریق شبانه خیس کننده
اگر فردی علائم B داشته باشد، معمولاً به این معنی است که لنفوم پیشرفتهتر است و اغلب درمان فشردهتری توصیه میشود. اگر علائم B وجود نداشته باشد، حرف A به مرحله اضافه میشود.
لنفوم هوچکین مقاوم (Resistant) یا عود کننده (recurrent)
HL مقاوم یا عود کننده بخشی از سیستم مرحله بندی رسمی نیست اما پزشکان یا پرستاران ممکن است از این اصطلاحات برای توصیف آن چه در لنفوم میگذرد، استفاده کنند.
- اصطلاحات بیماری مقاوم یا پیشرونده (progressive) زمانی استفاده میشود که لنفوم در حین درمان از بین نرود یا پیشرفت کند (رشد کند).
- بیماری عود کننده یا بازگشت کننده (relapsed) به این معنی است که HL با درمان از بین رفت اما اکنون عود کرده است. اگر لنفوم برگردد، ممکن است در همان جایی که شروع شده یا در قسمت دیگری از بدن باشد. این میتواند مدت کوتاهی پس از درمان یا سالها بعد اتفاق بیفتد.
میزان بقا برای لنفوم هوچکین
میزان بقا میتواند به شما این ایده را بدهد که چند درصد از افراد مبتلا به همان نوع و مرحله سرطان تا مدت معینی (معمولاً 5 سال) پس از تشخیص هنوز زنده هستند. آنها نمیتوانند به شما بگویند که چقدر زنده خواهید ماند اما ممکن است به شما کمک کنند تا درک بهتری در مورد احتمال موفقیت روند درمان خود داشته باشید.
به خاطر داشته باشید که میزان بقا تخمینی است و اغلب بر اساس نتایج قبلی تعداد زیادی از افرادی است که سرطان خاصی داشتند اما آنها نمیتوانند پیش بینی کنند که در مورد فرد خاصی چه اتفاقی خواهد افتاد.
این آمار میتواند گیج کننده باشد و ممکن است شما را به پرسیدن سوالات بیشتری سوق دهد. از پزشک خود که با شرایط شما آشنایی دارد، بپرسید که چگونه این اعداد ممکن است برای شما اعمال شوند.
نرخ بقای نسبی 5 ساله چیست؟
نرخ بقای نسبی، افراد با همان مرحله لنفوم هوچکین را با افراد موجود در کل جمعیت مقایسه میکند. به عنوان مثال، اگر میزان بقای 5 ساله برای مرحله خاصی از لنفوم هوچکین 80 درصد باشد، به این معنی است که احتمال زنده مانی افرادی که به آن سرطان مبتلا هستند برای ۵ سال پس از تشخیص ابتلا به بیماری نبست به افرادی که به آن سرطان مبتلا نیستند، به طور متوسط 80 درصد است.
این اعداد از کجا میآیند؟
انجمن سرطان آمریکا برای ارائه آمار بقای انواع مختلف سرطان به اطلاعات پایگاه داده نظارت، اپیدمیولوژی و نتایج نهایی (Surveillance, Epidemiology, and End Results یا SEER) که توسط موسسه ملی سرطان (National Cancer Institute یا NCI) نگهداری میشود، متکی است.
پایگاه داده SEER نرخ بقای نسبی 5 ساله لنفوم هوچکین در ایالات متحده را بر اساس میزان گسترش سرطان دنبال میکند. با این حال پایگاه داده SEER سرطانها را بر اساس طبقه بندی لوگانو (مرحله 1، مرحله 2، مرحله 3 و غیره) گروه بندی نمیکند. در عوض، سرطانها را به مراحل موضعی، منطقه ای و دور دسته بندی میکند:
- موضعی (Localized): سرطان به یک ناحیه غدد لنفاوی، یک اندام لنفاوی یا یک اندام خارج از سیستم لنفاوی محدود میشود.
- منطقه ای (Regional): سرطان از یک ناحیه غدد لنفاوی به اندام مجاور میرسد، در دو یا چند ناحیه غدد لنفاوی در یک سمت (بالا یا پایین) دیافراگم یافت میشود یا به عنوان بیماری حجیم در نظر گرفته میشود.
- دور (Distant): سرطان به قسمتهای دورتر بدن مانند ریهها، کبد یا مغز استخوان یا به نواحی غدد لنفاوی بالا و زیر دیافراگم گسترش یافته است.
نرخ بقای نسبی 5 ساله برای لنفوم هوچکین
این اعداد بر اساس اطلاعات افرادی است که بین سالهای 2012 تا 2018 به لنفوم هوچکین مبتلا شده اند.

درک اعداد
- این اعداد فقط برای مرحله سرطان در هنگام اولین تشخیص صدق میکند. اگر سرطان رشد کند، گسترش یابد یا پس از درمان عود کند، بعداً اعمال نمیشوند.
- این اعداد همه چیز را در نظر نمیگیرند. میزان بقا بر اساس میزان گسترش سرطان گروه بندی میشود اما سن و سلامت کلی شما، میزان پاسخگویی لنفوم به درمان و سایر عوامل پیش آگهی (که در زیر توضیح داده شده است) نیز میتوانند بر دیدگاه شما تأثیر بگذارند.
- افرادی که اکنون مبتلا به لنفوم هوچکین تشخیص داده شده اند، ممکن است چشم انداز بهتری نسبت به این اعداد داشته باشند. درمانها در طول زمان بهبود یافته اند و این اعداد بر اساس اطلاعات افرادی است که حداقل 5 سال زودتر تشخیص داده شده و درمان شده اند.
سایر عوامل پیش آگهی
همراه با مرحله لنفوم هوچکین، عوامل دیگری میتوانند بر پیش آگهی (دیدگاه) فرد تأثیر بگذارند. برای مثال، داشتن برخی از این عوامل به این معنی است که لنفوم احتمالاً جدیتر است:
- داشتن علائم B یا بیماری حجیم
- داشتن سن بالاتر از 45 سال
- مرد بودن
- داشتن تعداد گلبولهای سفید خون بالا (بیش از 15000)
- داشتن تعداد گلبولهای قرمز پایین (سطح هموگلوبین زیر 10 و نیم)
- داشتن تعداد کم لنفوسیت خون (زیر 600)
- داشتن سطح آلبومین خون پایین (زیر 4)
- داشتن نرخ رسوب گلبول قرمز بالا یا ESR (بیش از 30 در فردی با علائم B یا بیش از 50 برای فردی بدون علائم B)
برخی از این عوامل برای کمک به تقسیم لنفوم هوچکین مرحله I یا II به گروههای مطلوب و نامطلوب استفاده میشوند که میتواند بر شدت درمان تأثیر بگذارد.
درمان لنفوم هوچکین
اگر شما (یا فرزندتان) به لنفوم هوچکین (HL) مبتلا شده اید، تیم مراقبت از سرطان گزینههای درمانی را با شما در میان میگذارد. مهم است که در مورد انتخابهای خود با دقت فکر کنید. شما میخواهید مزایای هر گزینه درمانی را در مقابل خطرات و عوارض جانبی احتمالی بسنجید.
لنفوم هوچکین چگونه درمان میشود؟
شیمی درمانی و پرتو درمانی درمانهای اصلی برای HL هستند. بسته به مورد، یک یا هر دوی این درمانها ممکن است استفاده شود.
برخی از بیماران ممکن است با ایمونوتراپی یا پیوند سلولهای بنیادی تحت درمان قرار گیرند، به خصوص اگر سایر درمانها موثر واقع نشده باشند. به جز بیوپسی و مرحله بندی، جراحی به ندرت برای درمان HL استفاده میشود.
شیمی درمانی (Chemotherapy) برای لنفوم هوچکین
شیمی درمانی (chemo) استفاده از داروها برای از بین بردن سلولهای سرطانی است. شیمی درمانی معمولاً در رگ زیر پوست تزریق شده یا به صورت قرص مصرف میشود. داروهای شیمی درمانی وارد جریان خون میشوند و در سراسر بدن حرکت میکنند تا به سلولهای سرطانی در هر کجا که هستند برسند و آنها را از بین ببرند.
شیمی درمانی اصلی ترین درمان برای اکثر افراد مبتلا به لنفوم هوچکین است (به غیر از برخی از افراد مبتلا به لنفوم هوچکین با لنفوسیت ندولر یا NLPHL). گاهی اوقات شیمی درمانی با پرتو درمانی همراه است.
شیمی درمانی در چرخههایی تجویز میشود که شامل یک دوره درمان و به دنبال آن یک دوره استراحت برای دادن زمان به بدن برای بهبودی است. به طور کلی، هر سیکل چند هفته طول میکشد.
بیشتر شیمی درمانیها در مطب، کلینیک یا بخش سرپایی بیمارستان انجام میشوند، اما برخی ممکن است نیاز به بستری شدن در بیمارستان داشته باشند.
چه داروهای شیمی درمانی برای درمان لنفوم هوچکین استفاده میشود؟
شیمی درمانی برای لنفوم هوچکین کلاسیک (cHL) چندین دارو را ترکیب میکند زیرا داروهای مختلف سلولهای سرطانی را به روشهای مختلف از بین میبرند. ترکیبات مورد استفاده برای درمان cHL اغلب با اختصارات نامیده میشوند.
ABVD رایج ترین رژیم مورد استفاده در ایالات متحده است:
- آدریامایسین (doxorubicin)
- بلئومایسین (Bleomycin)
- وینبلاستین (Vinblastine)
- داکاربازین (DTIC)
سایر رژیمهای رایج عبارتند از:
BEACOPP
- بلئومایسین
- اتوپوزید (VP-16)
- آدریامایسین (دوکسوروبیسین)
- سیکلوفسفامید (Cyclophosphamide)
- اونکووین (vincristine)
- پروکاربازین (Procarbazine)
- پردنیزون (Prednisone)
استانفورد V (Stanford V)
- دوکسوروبیسین (آدریامایسین)
- مکلورتامین (nitrogen mustard)
- وین کریستین (Vincristine)
- وینبلاستین (Vinblastine)
- بلئومایسین
- اتوپوزید
- پردنیزون
پرتو درمانی پس از شیمی درمانی در رژیم Stanford V داده میشود. گاهی اوقات پس از رژیمهای ABVD یا BEACOPP نیز تجویز میشود.
سایر ترکیبات شیمی درمانی نیز میتوانند برای HL استفاده شوند. در بیشتر مواقع برخی از داروهای مشابه ذکر شده در بالا را استفاده میکنند اما ممکن است ترکیبات مختلفی داشته باشند و در برنامههای مختلف تجویز شوند.
داروی دیگری که میتواند به عنوان شیمی درمانی در نظر گرفته شود، برنتوکسیماب ودوتین (Adcetris) است. این یک ترکیب آنتی بادی-دارو (ADC) است که یک آنتی بادی مونوکلونال متصل به یک داروی شیمی درمانی است. برای اطلاعات بیشتر در مورد این دارو، مبحث ایمونوتراپی برای لنفوم هوچکین را مطالعه کنید.
عوارض جانبی احتمالی شیمی درمانی
داروهای شیمی درمانی میتوانند عوارض جانبی ایجاد کنند. اینها به نوع و دوز داروهای داده شده و مدت زمان درمان بستگی دارد. عوارض جانبی کوتاه مدت رایج عبارتند از:
- ریزش مو
- زخمهای دهانی
- از دست دادن اشتها
- تهوع و استفراغ
- اسهال
- افزایش احتمال عفونت (به دلیل داشتن گلبولهای سفید بسیار کم)
- کبودی یا خونریزی آسان (به دلیل داشتن تعداد بسیار کم پلاکت خون)
- خستگی (به دلیل داشتن گلبولهای قرمز بسیار کم)
این عوارض معمولا کوتاه مدت هستند و پس از پایان درمان به مرور زمان از بین میروند. در صورت بروز عوارض جانبی جدی، شیمی درمانی ممکن است به تعویق بیفتد یا دوزها کاهش یابد.
در صورت داشتن عوارض جانبی حتما به پزشک یا پرستار خود اطلاع دهید. اغلب راههایی برای کمک به آنها وجود دارد. به عنوان مثال، داروهایی اغلب برای کمک به جلوگیری از حالت تهوع و استفراغ استفاده میشوند.
عوارض جانبی دیر هنگام یا طولانی مدت: برخی از داروهای شیمی درمانی میتوانند عوارض جانبی طولانی مدت داشته باشند. برخی از این موارد ممکن است تا ماهها یا حتی سالها پس از پایان درمان رخ ندهند. مثلا:
- دوکسوروبیسین میتواند به قلب آسیب برساند، بنابراین پزشک ممکن است آزمایشاتی را برای بررسی عملکرد قلب شما قبل و در طول درمان با این دارو تجویز کند.
- بلئومایسین میتواند به ریهها آسیب برساند، بنابراین برخی از پزشکان قبل از شروع مصرف این دارو، آزمایشهای عملکرد ریه (به نام تستهای عملکرد ریوی یا pulmonary function tests) را تجویز میکنند.
- برخی از داروهای شیمی درمانی میتوانند خطر ابتلا به سرطان نوع دوم (مانند سرطان خون) را به ویژه در بیمارانی که پرتو درمانی نیز دریافت میکنند، افزایش دهند.
- در کودکان و بزرگسالان جوان، برخی از داروهای شیمی درمانی نیز میتوانند بر رشد بدن و باروری (توانایی بچه دار شدن) در آینده تأثیر بگذارند.
اثرات دراز مدت با جزئیات بیشتری در مبحث زندگی به عنوان یک بازمانده لنفوم هوچکین مورد بحث قرار گرفته است.
قبل از شروع شیمی درمانی، از پزشک خود بخواهید که عوارض جانبی احتمالی و احتمال بروز آنها را توضیح دهد. همچنین بپرسید چه کاری میتوانید برای جلوگیری از آنها انجام دهید.
پرتو درمانی (Radiation Therapy) برای لنفوم هوچکین
پرتو درمانی از پرتوهای پرانرژی (یا ذرات) برای از بین بردن سلولهای سرطانی استفاده میکند. پرتو درمانی بخشی از درمان برای اکثر افراد مبتلا به لنفوم هوچکین (HL) است. به ویژه زمانی مفید است که HL فقط در یک قسمت از بدن باشد.
برای لنفوم هوچکین کلاسیک، پرتو درمانی اغلب پس از شیمی درمانی داده میشود، به ویژه زمانی که توده تومور بزرگ یا حجیم (معمولاً در قفسه سینه) وجود داشته باشد. احتمالاً شیمی درمانی یا پرتو درمانی به تنهایی نمیتواند لنفوم را درمان کند اما هر دو درمان با هم معمولاً این کار را انجام میدهند.
پرتو درمانی همچنین میتواند به تنهایی برای درمان برخی از موارد لنفوم هوچکین غالب لنفوسیتی ندولار (NHLPL) استفاده شود.
پرتو درمانی اغلب در از بین بردن سلولهای HL بسیار خوب است اما با گذشت سالها مشخص شد که شیمی درمانی نیز بسیار خوب عمل میکند. امروزه، پزشکان به دلیل عوارض جانبی طولانی مدت احتمالی، تمایل دارند از اشعه کمتر و دوزهای کمتری از پرتو درمانی استفاده کنند. (مباحث زیر را مطالعه کنید.)
پرتو درمانی چگونه انجام میشود؟
برای درمان HL، پرتوهایی با دقت متمرکز شده از یک دستگاه ارسال میشود. به این پرتو درمانی خارجی (external beam radiation) میگویند.
قبل از شروع درمان، تیم پرتو اندازی اندازه گیریهای دقیقی برای تعیین زوایای هدف گیری پرتوها و دوز مورد نیاز انجام میدهند. این جلسه برنامه ریزی که شبیه سازی (simulation) نامیده میشود، معمولا شامل انجام تستهای تصویر برداری مانند CT یا PET اسکن است. ممکن است گچها، قالبهای بدن و تکیهگاههای سر ساخته شوند تا شما را در همان موقعیت برای هر درمان نگه دارند. ممکن است بلوکها یا سپرهایی برای محافظت از سایر قسمتهای بدن شما ساخته شوند.
ممکن است از شما خواسته شود که برای مدت کوتاهی نفس خود را حبس کنید. هدف این است که تابش را روی سرطان متمرکز کنیم تا تأثیر آن بر بافتهای سالم محدود شود.
اغلب، پرتو درمانی 5 روز در هفته به مدت چند هفته انجام میشود. روند درمان شباهت زیادی به گرفتن عکس اشعه ایکس دارد اما تابش قوی تر است. هر جلسه درمانی فقط چند دقیقه طول میکشد، اگرچه زمان تنظیم – قرار دادن شما یا فرزندتان در وضعیت مناسب برای انجام درمان- معمولاً بیشتر طول میکشد.
درمان بدون درد است اما برخی از کودکان کوچکتر ممکن است هنوز نیاز به آرام بخش داشته باشند تا مطمئن شوند که در طول درمان حرکت نمیکنند. تستهای تصویر برداری مدرن میتوانند محلهای HL را با دقت بسیار دقیق مشخص کنند که به پزشکان کمک میکند تا پرتو را فقط به سمت لنفوم هدف قرار دهند و در عین حال بافتهای طبیعی مجاور را حفظ کنند. این میتواند به محدود کردن عوارض جانبی کمک کند.
به یاد داشته باشید: غدد لنفاوی در سراسر بدن شما پراکنده هستند و لنفوم هوچکین میتواند در هر یک از آنها شروع شود. این بدان معناست که سرطان اغلب در نزدیکی اندامهای کلیدی مانند ریهها، قلب، کلیهها و نخاع و همچنین ماهیچهها قرار دارد. محافظت از عروق خونی و اعصاب و تمرکز تابش بر روی غدد لنفاوی برای محدود کردن آسیب به بافتهای سالم مجاور بسیار مهم است.
پرتو درمانی محل درگیر (ISRT یا Involved site radiation therapy)
بسیاری از پزشکان این رویکرد جدیدتر را برای پرتو درمانی هنگام درمان HL ترجیح میدهند. در ISRT، تابش فقط به غدد لنفاوی که در ابتدا حاوی لنفوم بودند و همچنین هر ناحیه نزدیکی که سرطان به آن گسترش یافته است، هدف قرار میگیرد. این کار اندازه ناحیه (یا میدان) درمان را کوچک میکند و به بافتها و اندامهای طبیعی مجاور برای محافظت در برابر تشعشعات کمک میکند.
پرتو درمانی میدانی درگیر (IFRT یا Involved field radiation therapy)
این شکل ترجیحی پرتو درمانی برای HL در گذشته بود اما اکنون تا حد زیادی با ISRT جایگزین شده است. در این تکنیک، تنها نواحی غدد لنفاوی که دارای HL هستند، درمان میشوند اما این شامل مناطق بزرگتری نسبت به ISRT میشود. (این میتواند خطر رسیدن اشعه به اندامهای مجاور را افزایش دهد.)
تشعشعات میدان گسترده (Extended field radiation)
امروزه این کار به ندرت انجام میشود اما قبلاً به نواحی اصلی غدد لنفاوی حاوی لنفوم و همچنین نواحی غدد لنفاوی طبیعی اطراف آن پرتو داده میشد. این کار فقط در صورت گسترش لنفوم انجام شد، حتی اگر پزشکان واقعاً نتوانستند آن را در این مناطق تشخیص دهند. به این تابش میدان گسترده (Extended field radiation) میگویند.
- اگر لنفوم در قسمت فوقانی بدن بود، تابش به میدان منتل (mantle field) داده میشد که شامل نواحی غدد لنفاوی در گردن، قفسه سینه و زیر بازوها میشد. گاهی اوقات این به غدد لنفاوی در بالای شکم (belly) نیز گسترش مییابد.
- پرتو درمانی میدان Y معکوس شامل غدد لنفاوی در قسمت فوقانی شکم، طحال و غدد لنفاوی در لگن بود.
- هنگامی که تابش میدان Y معکوس همراه با تابش میدان منتل داده شد، این ترکیب را تابش گرهی کل (total nodal irradiation) نامیدند.
از آن جایی که تقریباً تمام بیماران مبتلا به HL در حال حاضر با شیمی درمانی درمان میشوند، از پرتوهای میدان گسترده به ندرت دیگر استفاده میشود.
تابش کل بدن (Total body irradiation)
افرادی که پیوند سلولهای بنیادی را دریافت میکنند ممکن است همراه با شیمی درمانی با دوز بالا به کل بدن اشعه دریافت کنند تا سلولهای لنفوم را در سراسر بدن از بین ببرند. برای اطلاعات بیشتر در این مورد، مبحث شیمی درمانی با دوز بالا و پیوند سلولهای بنیادی را ببینید.
عوارض جانبی احتمالی پرتو درمانی
عوارض جانبی پرتو درمانی به این بستگی دارد که پرتو در کجا هدف قرار گرفته است.
برخی از اثرات احتمالی کوتاه مدت عبارتند از:
- تغییرات پوستی در نواحی تحت تابش، از قرمزی گرفته تا تاول و پوسته پوسته شدن
- احساس خستگی
- دهان خشک
- حالت تهوع
- اسهال
پرتوهای داده شده به چندین ناحیه، به ویژه پس از شیمی درمانی، میتواند تعداد سلولهای خونی را کاهش داده و خطر عفونت را افزایش دهد.
پرتو درمانی همچنین میتواند اثرات طولانی مدت داشته باشد، از جمله:
- افزایش خطر ابتلا به سرطان دیگری در بخشی از بدن که در معرض تشعشع قرار گرفته است.
- آسیب به غده تیروئید (از اشعه به قفسه سینه یا گردن) که میتواند بر توانایی آن در ساخت هورمون تیروئید تأثیر بگذارد. این میتواند منجر به خستگی و افزایش وزن شود.
- افزایش خطر بیماری قلبی (مانند حملات قلبی) و مشکلات ریوی از تابش اشعه به قفسه سینه
- افزایش خطر سکته مغزی سالها بعد پس از تشعشع به گردن
- کند شدن رشد استخوان در کودکان. بسته به جایی که تابش داده میشود، این میتواند باعث بدشکلی شده یا باعث شود کودک به قد کامل رشد نکند. تابش به قسمت پایین بدن در کودکان و بزرگسالان جوان نیز میتواند بر باروری در مراحل بعدی زندگی تأثیر بگذارد.
برای کاهش خطر عوارض جانبی، پزشکان دوز دقیق اشعه مورد نیاز را به دقت محاسبه کرده و پرتوهای تشعشعی را تا آن جا که میتوانند دقیق نشانه میگیرند. همچنین ممکن است سپرهایی روی قسمتهای نزدیک بدن قرار داده شود تا از آنها در برابر تشعشع محافظت کند. برای کمک به حفظ باروری در دختران و زنان جوان، ممکن است تخمدانها با جراحی جزئی قبل از پرتودهی از مسیر خارج شوند.
برای اطلاعات بیشتر، عوارض جانبی دیر هنگام و طولانی مدت درمان لنفوم هوچکین را ببینید. اگر شما یا فرزندتان پرتو درمانی میکنید، حتماً با پزشک خود در مورد عوارض جانبی احتمالی طولانی مدت صحبت کنید. لنفوم هوچکین قابل درمان است و عوارض جانبی طولانی مدت یک نگرانی بسیار واقعی است.
ایمونوتراپی (Immunotherapy) برای لنفوم هوچکین
ایمونوتراپی استفاده از داروها برای کمک به سیستم ایمنی فرد است تا سلولهای سرطانی را بهتر تشخیص دهد و از بین ببرد. ایمونوتراپی میتواند برای درمان برخی از افراد مبتلا به لنفوم هوچکین (HL) استفاده شود.
آنتی بادیهای مونوکلونال (Monoclonal antibodies)
آنتی بادیها پروتئینهایی هستند که توسط سیستم ایمنی بدن برای کمک به مبارزه با عفونتها ساخته میشوند.
نسخههای ساخته شده توسط انسان که آنتی بادیهای مونوکلونال (mAbs) نامیده میشوند، میتوانند برای حمله به یک هدف خاص، مانند ماده ای روی سطح لنفوسیتها (سلولهایی که HL در آنها شروع میشود) طراحی شوند.
برنتوکسیماب ودوتین (Brentuximab vedotin یا Adcetris)
سلولهای لنفوم هوچکین کلاسیک (cHL) معمولاً مولکول CD30 را روی سطح خود دارند. برنتوکسیماب ودوتین یک آنتی بادی ضد CD30 است که به یک داروی شیمی درمانی متصل است. آنتی بادی مانند یک سیگنال خانگی عمل میکند و داروی شیمی درمانی را با CD30 به سلولهای لنفوم میرساند. این دارو وارد سلولها میشود و زمانی که آنها سعی میکنند به سلولهای جدید تقسیم شوند آنها را میکشد.
از این دارو میتوان در موارد زیر استفاده کرد:
- به عنوان بخشی از اولین درمان در کودکان 2 سال یا بیشتر با cHL پرخطر همراه با شیمی درمانی.
- به عنوان بخشی از اولین درمان برای بزرگسالان مبتلا به مرحله III یا IV cHL، همراه با شیمی درمانی
- در بزرگسالان مبتلا به cHL که پس از درمانهای دیگر، از جمله پس از پیوند سلولهای بنیادی (یا در افرادی که به دلایلی نمیتوانند پیوند انجام دهند) بازگشته است. میتوان آن را به تنهایی یا همراه با شیمی درمانی داد.
- پس از پیوند سلولهای بنیادی برای بزرگسالان در معرض خطر بالای عود لنفوم پس از درمان. در این شرایط معمولا به مدت یک سال به خودی خود داده میشود.
برنتوکسیماب ودوتین معمولاً هر 2 یا 3 هفته یکبار در ورید (IV) تزریق میشود.
عوارض جانبی رایج میتواند شامل موارد زیر باشد:
- آسیب عصبی (نوروپاتی یا neuropathy)
- تعداد کم سلولهای خونی
- خستگی
- تب
- تهوع و استفراغ
- عفونتها
- اسهال
به ندرت، عوارض جانبی جدی در طول انفوزیون IV رخ میدهد، مانند مشکلات تنفسی و فشار خون پایین
ریتوکسیماب (Rituxan)
ریتوکسیماب ممکن است برای درمان لنفوم هوچکین غالب لنفوسیتی ندولار (NLPHL) استفاده شود. این mAb به ماده ای به نام CD20 روی برخی از انواع سلولهای لنفوم میچسبد. اغلب همراه با شیمی درمانی و یا پرتو درمانی داده میشود.
ریتوکسیماب به صورت انفوزیون IV در مطب یا کلینیک پزشک تجویز میشود. هنگامی که به تنهایی استفاده میشود، معمولاً یک بار در هفته به مدت 4 هفته تجویز میشود که ممکن است چندین ماه بعد تکرار شود. هنگامی که همراه با شیمی درمانی داده میشود، اغلب در روز اول هر سیکل شیمی درمانی داده میشود.
عوارض جانبی رایج معمولاً خفیف هستند اما میتوانند شامل موارد زیر باشند:
- لرز
- تب
- حالت تهوع
- بثورات
- خستگی
- سردرد
به ندرت، عوارض جانبی شدیدتری در حین انفوزیون رخ میدهد، مانند مشکلات تنفسی و فشار خون پایین. قبل از هر جلسه درمانی دارویی به شما داده میشود تا از این اتفاق جلوگیری شود اما حتی اگر این علائم در اولین انفوزیون رخ دهند، تکرار آنها با دوزهای بعدی غیر عادی است.
ریتوکسیماب میتواند باعث فعال شدن مجدد عفونتهای قبلی هپاتیت B شود که گاهی منجر به مشکلات شدید کبدی یا حتی مرگ میشود. احتمالاً پزشک قبل از شروع این دارو، خون شما را برای علائم هپاتیت بررسی میکند.
ریتوکسیماب همچنین میتواند خطر عفونت را برای چندین ماه پس از قطع دارو افزایش دهد.
مهار کنندههای ایست بازرسی ایمنی (Immune checkpoint inhibitors)
بخش مهمی از سیستم ایمنی، توانایی آن در جلوگیری از حمله به سلولهای طبیعی بدن است. برای انجام این کار، از پروتئینهای «نقطه بازرسی یا checkpoint» استفاده میکند که مانند سوئیچهایی روی سلولهای ایمنی عمل میکنند که باید برای شروع پاسخ ایمنی روشن (یا خاموش شوند). سلولهای سرطانی گاهی اوقات از این نقاط بازرسی برای جلوگیری از حمله سیستم ایمنی استفاده میکنند.
Nivolumab (Opdivo) و Pembrolizumab (Keytruda) مهار کنندههای ایست بازرسی هستند که میتوانند در افراد مبتلا به لنفوم هوچکین کلاسیک که سرطان آنها در طول درمان رشد کرده است (به نام سرطان مقاوم) یا پس از آزمایش سایر درمانها (به نام سرطان عود کننده) بازگشته است، استفاده شود.
این داروها PD-1 را هدف قرار میدهند، پروتئینی روی سلولهای خاص سیستم ایمنی (به نام سلولهای T) که به طور معمول به جلوگیری از حمله این سلولها به سلولهای دیگر بدن کمک میکند. این داروها با مسدود کردن PD-1، پاسخ ایمنی در برابر سلولهای سرطانی را تقویت میکنند. این میتواند برخی از تومورها را کوچک کرده یا رشد آنها را کند کند.
این داروها به صورت انفوزیون داخل وریدی (IV) معمولاً هر 2، 3 یا 6 هفته تجویز میشوند.
عوارض جانبی احتمالی
عوارض جانبی این داروها میتواند شامل موارد زیر باشد:
- خستگی
- تب
- سرفه
- حالت تهوع
- خارش
- بثورات پوستی
- از دست دادن اشتها
- درد مفاصل
- یبوست
- اسهال
سایر عوارض جانبی جدی تر کمتر رخ میدهد.
واکنشهای انفوزیون (Infusion reactions): برخی از افراد ممکن است در حین مصرف یکی از این داروها، واکنش انفوزیون داشته باشند. این مانند یک واکنش آلرژیک است و میتواند شامل تب، لرز، برافروختگی صورت، بثورات پوستی، خارش پوست، احساس سرگیجه، خس خس سینه و مشکل در تنفس باشد. مهم است که در صورت داشتن هر یک از این علائم در حین مصرف یکی از این داروها، فوراً به پزشک یا پرستار خود اطلاع دهید.
واکنشهای خود ایمنی (Autoimmune reactions): این داروها اساساً با حذف یکی از محافظهای سیستم ایمنی بدن عمل میکنند. گاهی اوقات سیستم ایمنی شروع به حمله به سایر قسمتهای بدن میکند که میتواند باعث مشکلات جدی یا حتی تهدید کننده زندگی در ریهها، رودهها، کبد، غدد هورمون ساز، کلیهها یا سایر اندامها شود.
اگر متوجه هر گونه مشکلی شدید، باید فوراً آن را به تیم مراقبتهای بهداشتی خود اطلاع دهید. در صورت بروز عوارض جانبی جدی، ممکن است لازم باشد درمان قطع شود و ممکن است دوزهای بالایی از استروئیدها (steroids) را برای سرکوب سیستم ایمنی خود دریافت کنید.
شیمی درمانی با دوز بالا (High-dose Chemotherapy) و پیوند سلولهای بنیادی (Stem Cell Transplant) برای لنفوم هوچکین
پیوند سلولهای بنیادی (SCTs) گاهی اوقات برای درمان سخت لنفوم هوچکین، مانند بیماری که پس از شیمی درمانی (chemo) یا پرتو درمانی به طور کامل از بین نمیرود و یا لنفومی که پس از درمان عود میکند، استفاده میشود.
دوز داروهای شیمی درمانی که به بیماران داده میشود معمولاً به دلیل عوارض جانبی این داروها محدود است. دوزهای بالاتر را نمیتوان استفاده کرد، حتی اگر ممکن است سلولهای سرطانی بیشتری را از بین ببرند زیرا به مغز استخوان – جایی که سلولهای خونی جدید ساخته میشوند – به شدت آسیب میرساند.
پیوند سلولهای بنیادی به پزشکان اجازه میدهد دوزهای بالاتری از شیمی درمانی (گاهی اوقات همراه با پرتو درمانی) را تجویز کنند. این به این دلیل است که پس از دریافت شیمی درمانی با دوز بالا، بیمار پیوند سلولهای بنیادی خون ساز را برای بازسازی مغز استخوان دریافت میکند.
سلولهای بنیادی خونساز مورد استفاده برای پیوند میتوانند از خون یا از مغز استخوان به دست آیند. امروزه بیشتر پیوندها با سلولهایی انجام میشود که از خون خارج میشوند و به آنها پیوند سلولهای بنیادی محیطی (peripheral stem cell transplants) میگویند.
انواع پیوند
2 نوع اصلی پیوند سلولهای بنیادی وجود دارد. آنها از منابع مختلف سلولهای بنیادی خون ساز استفاده میکنند.
- در پیوند سلولهای بنیادی اتولوگ (autologous stem cell transplant)، سلولهای بنیادی خون خود بیمار چندین بار در هفتههای قبل از درمان جمع آوری میشود. سلولها در زمانی که فرد تحت درمان قرار میگیرد (شیمی درمانی با دوز بالا و یا پرتو درمانی) منجمد و ذخیره شده و سپس توسط یک IV به خون بیمار بازگردانده میشوند. این رایج ترین نوع پیوند برای لنفوم هوچکین است.
- در پیوند سلولهای بنیادی آلوژنیک (allogeneic stem cell transplant)، سلولهای بنیادی خون از شخص دیگری میآیند. معمولاً این یک برادر یا خواهر است اما منبع میتواند اهدا کننده غیر مرتبط یا خون بند ناف باشد. نوع بافت دهنده (همچنین به عنوان نوع HLA شناخته میشود) باید تا حد امکان با نوع بافت بیمار مطابقت داشته باشد تا از مشکلات عمده در پیوند جلوگیری شود. معمولاً در درمان لنفوم هوچکین، پیوند آلوژنیک تنها در صورتی استفاده میشود که پیوند اتولوگ قبلاً بدون موفقیت آزمایش شده باشد.
پیوند سلولهای بنیادی یک درمان پیچیده است که میتواند عوارض جانبی تهدید کننده زندگی ایجاد کند. اگر پزشکان فکر میکنند که یک فرد ممکن است از پیوند سود ببرد، باید در یک مرکز سرطان که کارکنان آن در این روش و مدیریت مرحله بهبودی تجربه دارند، انجام شود.
درمان لنفوم کلاسیک هوچکین، بر اساس مرحله
این بخش گزینههای درمانی لنفوم هوچکین (HL) در بزرگسالان را بر اساس مرحله سرطان خلاصه میکند. درمان این بیماری در کودکان کمی با درمان بزرگسالان متفاوت است. برخی از این تفاوتها در مطلب درمان لنفوم هوچکین در کودکان مورد بحث قرار گرفته است. برای نوجوانان مبتلا به HL که به طور کامل رشد کرده اند، درمان معمولاً مانند بزرگسالان است.
گزینههای درمانی به عوامل زیادی بستگی دارد، از جمله:
- نوع HL
- مرحله (وسعت) HL
- حجیم بودن یا نبودن بیماری (بزرگ بودن)
- آیا بیماری باعث ایجاد علائم B میشود یا خیر.
- نتایج آزمایشات خون و سایر تستهای آزمایشگاهی
- سن فرد
- سلامت کلی فرد
- ترجیحات شخصی
بر اساس این عوامل، درمان یک فرد ممکن است کمی متفاوت از طرح کلی زیر باشد.
اکثر متخصصان موافقند که درمان در یک کارآزمایی بالینی باید برای HL در نظر گرفته شود که به درمان مقاوم است یا پس از درمان عود میکند.
مراحل IA و IIA، مطلوب
این گروه شامل HL است که فقط در یک طرف دیافراگم (بالا یا پایین) قرار دارد و هیچ عامل نامطلوبی ندارد. مثلا:
- حجیم نیست.
- HL در کمتر از 3 ناحیه غدد لنفاوی مختلف است.
- هیچ یک از علائم B را ایجاد نمیکند.
- ESR (سرعت رسوب گلبول قرمز) بالا نیست.
درمان برای بسیاری از بیماران، شیمی درمانی است (معمولاً 2 تا 4 دوره از رژیم ABVD) و به دنبال آن پرتو درمانی به محل اولیه بیماری (پرتو درمانی محل درگیر یا ISRT) است. گزینه دیگر شیمی درمانی به تنهایی (معمولاً برای 3 تا 6 سیکل) در بیماران منتخب است.
پزشکان اغلب پس از چند دوره شیمی درمانی، اسکن PET/CT را انجام میدهند تا ببینند روند درمان چقدر خوب کار میکند و تعیین کنند که چقدر به درمان بیشتری (در صورت وجود) نیاز است.
اگر فردی به دلیل سایر مشکلات سلامتی نمیتواند شیمی درمانی کند، پرتو درمانی به تنهایی ممکن است یک گزینه باشد.
برای کسانی که به درمان پاسخ نمیدهند، ممکن است شیمی درمانی با استفاده از داروهای مختلف یا شیمی درمانی با دوز بالا (و احتمالاً پرتو درمانی) و به دنبال آن پیوند سلولهای بنیادی توصیه شود. درمان با یک داروی ایمونوتراپی مانند brentuximab vedotin (Adcetris)، nivolumab (Opdivo) یا pembrolizumab (Keytruda) ممکن است گزینه دیگری باشد.
مراحل I و II نامطلوب
این گروه شامل HL است که فقط در یک طرف دیافراگم (بالا یا پایین) قرار دارد اما دارای 1 یا بیشتر از این عوامل خطرزا است:
- حجیم است (تومور بزرگ است).
- HL در 3 یا بیشتر ناحیه مختلف غدد لنفاوی است.
- سرطانی در خارج از غدد لنفاوی وجود دارد (به نام درگیری خارج گرهی یا extranodal involvement)
- باعث ایجاد علائم B میشود.
- ESR (نرخ رسوب گلبول قرمز) بالاست.
درمان عموماً شدیدتر از درمان بیماری مطلوب است.
معمولاً با شیمی درمانی (معمولاً با رژیم ABVD برای 4 تا 6 سیکل یا سایر رژیمها مانند 3 دوره استنفورد V) شروع میشود.
اسکن PET/CT اغلب پس از چندین دوره شیمی درمانی انجام میشود تا مشخص شود که آیا (و چقدر) به درمان بیشتری نیاز است یا خیر. این اغلب با شیمی درمانی بیشتر و شاید روش متفاوتی دنبال میشود. پرتو درمانی (پرتو درمانی شامل پرتو درمانی میدانی یا IFRT) معمولاً در این نقطه به محل تومور داده میشود، به خصوص اگر بیماری حجیم باشد.
برای کسانی که به درمان پاسخ نمیدهند، ممکن است شیمی درمانی با استفاده از داروهای مختلف یا شیمی درمانی با دوز بالا (و احتمالاً پرتو) و به دنبال آن پیوند سلولهای بنیادی توصیه شود. درمان با یک داروی ایمونوتراپی مانند brentuximab vedotin (Adcetris)، nivolumab (Opdivo) یا pembrolizumab (Keytruda) ممکن است گزینه دیگری باشد.
مراحل III و IV
این شامل HL است که هم در بالا و هم در زیر دیافراگم قرار دارد و یا به طور گسترده از طریق یک یا چند اندام خارج از سیستم لنفاوی پخش شده است.
پزشکان معمولاً این مراحل را با شیمی درمانی با استفاده از رژیمهای شدیدتر نسبت به مراحل اولیه درمان میکنند. رژیم ABVD (برای حداقل 6 سیکل) اغلب استفاده میشود اما برخی از پزشکان از درمان شدیدتر با رژیم Stanford V برای 3 سیکل یا تا 8 دوره از رژیم BEACOPP در صورت وجود چندین فاکتور پیش آگهی نامطلوب استفاده میکنند. گزینه دیگر برای برخی افراد ممکن است شیمی درمانی به همراه داروی برنتوکسیماب ودوتین (Adcetris) باشد.
اسکن PET/CT ممکن است در طول یا بعد از شیمی درمانی برای ارزیابی میزان درمان بیشتر مورد نیاز شما استفاده شود. بسته به نتایج اسکن، ممکن است شیمی درمانی بیشتری داده شود. رادیوتراپی ممکن است بعد از شیمی درمانی انجام شود، به خصوص اگر ناحیه تومور بزرگی وجود داشته باشد.
برای کسانی که HL آنها به درمان پاسخ نمیدهد، ممکن است شیمی درمانی با استفاده از داروهای مختلف یا شیمی درمانی با دوز بالا (و احتمالاً پرتو درمانی) و به دنبال آن پیوند سلولهای بنیادی توصیه شود. درمان با یک داروی ایمونوتراپی مانند brentuximab vedotin (Adcetris)، nivolumab (Opdivo) یا pembrolizumab (Keytruda) ممکن است گزینه دیگری باشد.
لنفوم هوچکین مقاوم یا refractory
درمان HL باید تمام آثار لنفوم را حذف کند. پس از درمان، پزشک آزمایشاتی مانند اسکن PET/CT را برای بررسی علائم HL انجام میدهد. اگر HL هنوز وجود داشته باشد، اکثر متخصصان فکر میکنند که بعید به نظر میرسد درمان مشابه بیشتر آن را درمان کند.
گاهی اوقات، پرتو درمانی در ناحیهای از بیماری که پس از شیمی درمانی باقی میماند ممکن است روش درمانی باشد. استفاده از ترکیب متفاوتی از داروهای شیمی درمانی گزینه دیگری است. اگر پرتو درمانی به تنهایی درمان اولیه بود، استفاده از شیمی درمانی (با پرتو درمانی بیشتر یا بدون آن) نیز ممکن است درمانی باشد.
اگر بعد از این درمانها همچنان HL وجود داشته باشد، اکثر پزشکان شیمی درمانی با دوز بالا (و احتمالاً پرتو درمانی) و سپس پیوند سلولهای بنیادی اتولوگ را توصیه میکنند. اگر بعد از این مدت سرطان همچنان باقی بماند، پیوند سلولهای بنیادی آلوژنیک ممکن است یک گزینه باشد.
گزینه دیگر، به جای یا بعد از پیوند سلولهای بنیادی، ممکن است درمان با یک داروی ایمونوتراپی مانند برنتوکسیماب ودوتین (Adcetris)، نیولوماب (Opdivo)، یا پمبرولیزوماب (Keytruda) باشد.
لنفوم هوچکین عود کننده یا relapsed
اگر HL بعد از درمان برگشت (عود کرد)، درمان بیشتر به محل بازگشت لنفوم، مدت زمان از درمان اولیه و اینکه درمان اولیه چه بوده بستگی دارد.
اگر درمان اولیه تنها پرتو درمانی بود، معمولاً برای بیماری عود کننده شیمی درمانی انجام میشود.
اگر ابتدا از شیمی درمانی بدون پرتو درمانی استفاده شده باشد و سرطان فقط در غدد لنفاوی عود کند، پرتو درمانی به غدد لنفاوی را میتوان با شیمی درمانی بیشتر یا بدون آن انجام داد. شیمی درمانی با داروهای مختلف ممکن است گزینه دیگری باشد.
تابش معمولاً در همان ناحیه قابل تکرار نیست. به عنوان مثال، اگر HL در قفسه سینه با پرتو درمانی درمان شد و در قفسه سینه برگشت، معمولاً نمیتوان با تشعشع بیشتر به قفسه سینه آن را درمان کرد. این موضوع صرف نظر از مدتی که تابش برای اولین بار داده شده است، صادق است.
اگر لنفوم پس از سالها عود کند، استفاده از داروهای شیمی درمانی مشابه یا متفاوت (احتمالا همراه با پرتو) ممکن است آن را درمان کند. از سوی دیگر، HL که بلافاصله پس از درمان عود میکند، ممکن است به درمان فشرده تری نیاز داشته باشد. به عنوان مثال، اگر HL در عرض چند ماه پس از درمان اولیه بازگشته باشد، ممکن است شیمی درمانی با دوز بالا (و احتمالاً تشعشع) و سپس پیوند سلولهای بنیادی اتولوگ توصیه شود.
اگر HL همچنان پس از پیوند اتولوگ باقی بماند، پیوند سلولهای بنیادی آلوژنیک ممکن است یک گزینه باشد. گزینه دیگر، به جای پیوند سلولهای بنیادی یا بعد از آن، ممکن است درمان با یک داروی ایمونوتراپی مانند برنتوکسیماب ودوتین (Adcetris)، نیولوماب (Opdivo)، یا پمبرولیزوماب (Keytruda) باشد.
درمان لنفوم هوچکین با لنفوسیت ندولار
لنفوم هوچکین غالب با لنفوسیت ندولار (NLPHL) یک نوع نادر از لنفوم هوچکین (HL) است که نسبت به HL کلاسیک (cHL) تمایل به رشد کندتری دارد و اغلب به طور متفاوتی با آن برخورد میشود.
برای افراد مبتلا به NLPHL در مراحل اولیه بدون هیچ گونه علائم B، پرتو درمانی در محل (ISRT) اغلب تنها چیزی است که مورد نیاز است.
گزینه دیگری برای برخی افراد ممکن است این باشد که ابتدا لنفوم را به دقت زیر نظر داشته باشند و سپس با ظاهر شدن علائم، درمان را شروع کنند.
اگر NLPHL در مراحل اولیه حجیم (بزرگ) باشد یا علائم B را ایجاد کند، درمان اصلی معمولاً شیمی درمانی و به دنبال آن پرتو درمانی (ISRT) است. بسیاری از پزشکان از رژیم شیمی درمانی ABVD استفاده میکنند اما برخی از پزشکان رژیمهای دیگر را ترجیح میدهند. آنتی بادی مونوکلونال ریتوکسیماب (Rituxan) ممکن است همراه با شیمی درمانی داده شود. برای اطلاعات بیشتر در مورد ریتوکسیماب به مبحث ایمونوتراپی برای لنفوم هوچکین مراجعه کنید.
اگر NLPHL پیشرفته تر باشد (مرحله III یا IV)، احتمالاً شیمی درمانی با پرتو درمانی (ISRT) یا بدون آن و یا ریتوکسیماب توصیه میشود. به برخی از بیماران بدون علائم B ممکن است به تنهایی ریتوکسیماب داده شود.
داروهای شیمی درمانی مورد استفاده برای NLPHL
Chemo برای NLPHL همیشه با آن چه برای cHL استفاده میشود یکسان نیست، اگرچه چندین دارو را نیز ترکیب میکند زیرا داروهای مختلف سلولهای سرطانی را به روشهای مختلف از بین میبرند. ترکیبات مورد استفاده برای درمان NLPHL اغلب با اختصارات نامیده میشوند. در اینجا رایج ترین ترکیبات مورد استفاده در ایالات متحده وجود دارد. Rituximab را میتوان به هر یک از آنها اضافه کرد.
ABVD (همچنین برای cHL استفاده میشود)
- آدریامایسین (دوکسوروبیسین)
- بلئومایسین
- وینبلاستین
- داکاربازین (DTIC)
CHOP
- سیکلوفسفامید (Cytoxan®)
- دوکسوروبیسین
- وین کریستین (Oncovin®)
- پردنیزون
CVP
- سیکلوفسفامید
- وینبلاستین
- پردنیزون
درمان لنفوم هوچکین در کودکان
درمان لنفوم هوچکین (HL) در کودکان اندکی با درمان بزرگسالان متفاوت است. همان طور که برای بزرگسالان، هدف اصلی در درمان HL در کودکان، درمان لنفوم بدون ایجاد مشکلات طولانی مدت است. پزشکان درمان را بر اساس سن کودک، وسعت لنفوم، میزان پاسخگویی لنفوم به درمان و سایر عوامل تنظیم میکنند.
اگر کودک از بلوغ گذشته باشد و ماهیچهها و استخوانها کاملاً رشد کرده باشند، درمان معمولاً مانند درمان بزرگسالان است اما اگر کودک به اندازه کامل بدن خود نرسیده باشد، شیمی درمانی (chemo) احتمالاً بر پرتو درمانی ترجیح داده میشود. این به این دلیل است که تشعشعات میتوانند بر رشد استخوان و ماهیچه تأثیر بگذارند و کودکان را از رسیدن به اندازه طبیعی خود باز دارد.
بدن کودکان تمایل دارد شیمی درمانی را در کوتاه مدت بهتر از بزرگسالان تحمل کند. اما برخی از عوارض جانبی بیشتر در کودکان رخ میدهد. از آن جایی که برخی از این عوارض جانبی ممکن است طولانی مدت باشند یا ممکن است تا سالها بعد رخ ندهند، کودکانی که از سرطان جان سالم به در میبرند تا پایان عمر خود نیاز به توجه دقیق دارند.
از دهه 1960، اکثر کودکان و نوجوانان مبتلا به سرطان در مراکز ویژه ای که برای آنها طراحی شده است، درمان میشوند. درمان در این مراکز این مزیت را دارد که تیمی از متخصصان با تجربه در زمینه تفاوتهای سرطان بزرگسالان و کودکان و همچنین نیازهای منحصر به فرد کودکان مبتلا به سرطان و خانوادههایشان را داشته باشند. این تیم معمولاً شامل انکولوژیستهای اطفال، جراحان، انکولوژیستهای پرتو شناسی، پاتولوژیستها، پرستاران انکولوژی اطفال و پزشکان پرستار میباشد.
مراکز سرطان کودکان همچنین دارای روانشناس، مددکار اجتماعی، متخصص زندگی کودک، متخصص تغذیه، توانبخشی و فیزیوتراپی و مربیانی هستند که میتوانند از کل خانواده حمایت کنند.
اکثر کودکان مبتلا به سرطان در ایالات متحده در مرکزی که عضو گروه انکولوژی کودکان (Children’s Oncology Group یا COG) است، درمان میشوند. همه این مراکز با یک دانشگاه یا بیمارستان کودکان مرتبط هستند. همان طور که در مورد درمان سرطان دوران کودکی بیشتر آموختیم، انجام درمان توسط متخصصان در این زمینه اهمیت بیشتری پیدا کرده است.
در این مراکز، پزشکان معالج کودکان مبتلا به HL اغلب از طرحهای درمانی استفاده میکنند که بخشی از آزمایشات بالینی است. هدف از این مطالعات یافتن بهترین درمانهایی است که کمترین عوارض جانبی را ایجاد میکنند.
هر زمان که کودک یا نوجوانی مبتلا به سرطان تشخیص داده میشود، این سرطان بر هر عضو خانواده و تقریباً هر جنبهای از زندگی خانواده تأثیر میگذارد.
درمان لنفوم کلاسیک هوچکین (cHL) در کودکان
هنگام درمان کودکان مبتلا به لنفوم هوچکین کلاسیک (cHL)، پزشکان اغلب شیمی درمانی (chemo) را با دوزهای پایین پرتوها ترکیب میکنند. شیمی درمانی اغلب شامل ترکیبی از بسیاری از داروها به جای رژیم معمول ABVD بزرگسالان است، به ویژه برای لنفومهایی که ویژگیهای نامطلوب دارند یا پیشرفته تر هستند. در برخی شرایط، ترکیب آنتی بادی-دارو برنتوکسیماب ودوتین (Adcetris) ممکن است در رژیم شیمی درمانی نیز گنجانده شود.
این رویکرد حتی برای کودکان مبتلا به بیماری پیشرفتهتر، نرخ موفقیت بسیار خوبی داشته است.
مراحل IA و IIA، مطلوب
درمان به طور کلی با شیمی درمانی به تنهایی شروع میشود که در کمترین دوز استفاده میشود که احتمالاً منجر به درمان میشود. اسکن PET ممکن است برای بررسی این که آیا درمان موثر است و یا این که آیا لنفوم در بدن باقی مانده است، استفاده شود. اگر HL به طور کامل از بین نرود، ممکن است به پرتو درمانی یا شیمی درمانی بیشتری نیاز باشد.
مطالعات نشان داده اند که HL در کودکان بدون استفاده از اشعه قابل درمان است. این از مشکلات طولانی مدتی که میتواند ایجاد کند جلوگیری میکند اما در صورت استفاده از پرتو درمانی، دوز و ناحیه تحت درمان تا حد امکان کوچک نگه داشته میشود.
اگر در دختران و زنان جوان از تابش در قسمت تحتانی بدن استفاده شود، برای کمک به حفظ باروری باید از تخمدانها محافظت شود.
مراحل I و II نامطلوب
احتمالاً درمان شامل یک رژیم شیمی درمانی شدیدتر است که در برخی موارد ممکن است شامل برنتوکسیماب ودوتین باشد. پرتو درمانی نیز احتمالاً انجام خواهد شد اما دوز و میدان پرتو تا حد امکان کوچک نگه داشته میشود.
مراحل III و IV
درمان این لنفومهای پیشرفته تر معمولاً با شیمی درمانی شدیدتر شروع میشود که ممکن است شامل برنتوکسیماب ودوتین باشد. پرتو درمانی ممکن است در مناطقی با بیماری حجیم (مناطق حاوی لنفوم زیاد) انجام شود.
cHL عود کننده یا مقاوم
اگر لنفوم عود کند یا دیگر به درمان پاسخ ندهد، ممکن است انواع مختلفی از رژیمهای شیمی درمانی را امتحان کنید. گزینههای دیگر ممکن است شامل پیوند سلولهای بنیادی یا درمان با داروی ایمونوتراپی (گاهی همراه با شیمی درمانی) باشد.
درمان لنفوم هوچکین با لنفوسیت ندولر در کودکان
لنفوم هوچکین غالب با لنفوسیت ندولار (NLPHL) در کودکان بسیار نادر است. هیچ چیزی به نام بهترین درمان واحد وجود ندارد و درمانهای مورد استفاده اغلب شبیه درمانهای مورد استفاده برای درمان cHL و یا درمانهای مورد استفاده برای درمان NLPHL بزرگسالان هستند.
یک استثنا وجود دارد: در مراحل اولیه NLPHL در کودکان، جراحی برای برداشتن غده لنفاوی آسیب دیده ممکن است تنها درمان مورد نیاز باشد. پس از جراحی، این کودکان از نظر علائم لنفوم به دقت تحت نظر هستند. در صورت بازگشت میتوان از Chemo استفاده کرد.
درمان لنفوم هوچکین در دوران بارداری
اگر زنی باردار باشد و لنفوم هوچکین (HL) تشخیص داده شود، گزینههای درمانی به عوامل مختلفی بستگی دارد. زن و پزشکان او (از جمله متخصص زنان و زایمان او) باید در مورد وسعت یا مرحله لنفوم، سرعت رشد آن، مدت زمان بارداری و ترجیحات شخصی خود زن فکر کنند.
اگر لنفوم هوچکین در دوران بارداری نیاز به درمان داشته باشد، در صورت امکان تا سه ماهه اول بارداری به تعویق میافتد. این به این دلیل است که خطرات برای نوزاد پس از 3 ماه اول کمتر است. درمان معمولاً شیمی درمانی با استفاده از یک یا چند دارو (اغلب ترکیبی از ABVD) بر اساس هر مورد است.
اگر لنفوم هوچکین در نیمه دوم بارداری تشخیص داده شود و مشکلی ایجاد نکند، یک زن اغلب میتواند قبل از شروع درمان صبر کند تا نوزاد متولد شود. این روش برای نوزاد ایمن ترین است. (گاهی اوقات زایمان چند هفته زودتر القا میشود و درمان بلافاصله شروع میشود.)
پرتو درمانی اغلب در دوران بارداری به دلیل نگرانی در مورد اثرات طولانی مدت احتمالی بر جنین متولد نشده انجام نمیشود. همه متخصصان موافق نیستند اما برخی میگویند تا زمانی که اقدامات احتیاطی بسیار دقیق برای هدف گیری دقیق پرتو، محدود کردن دوزها و محافظت از نوزاد انجام شود، زنان باردار مبتلا به HL در غدد لنفاوی گردن، ناحیه زیر بغل یا داخل قفسه سینه میتوانند اشعه را با خطر کم یا بدون خطر برای کودک دریافت کند. اگر تشعشع داده شود، در صورت امکان باید حداقل تا سه ماهه دوم به تعویق بیفتد. تا به امروز، مطالعات نشان نداده اند که تأخیر در پرتو درمانی برای مادر مضر است.
نیاز به اجتناب از تشعشع همچنین محدودیتهایی را برای آزمایشهای تصویر برداری برای کمک به تعیین مرحله (وسعت) لنفوم و مشاهده اینکه آیا درمان مؤثر است، محدود میکند. سی تی اسکن، اسکن PET و اشعه ایکس همگی از اشعه استفاده میکنند، بنابراین در صورت امکان از آنها اجتناب میشود. به جای آن میتوان از اسکن MRI و سونوگرافی استفاده کرد.
زندگی به عنوان یک بازمانده لنفوم هوچکین
برای بسیاری از افراد مبتلا به لنفوم هوچکین (HL)، روشهای درمانی میتواند لنفوم را معالجه کند. تکمیل درمان میتواند هم استرس زا و هم هیجان انگیز باشد. ممکن است با اتمام درمان راحت شوید اما نگران بازگشت لنفوم نباشید. (زمانی که سرطان پس از درمان باز میگردد، عود نامیده میشود.) اگر سرطان داشته باشید، این یک نگرانی بسیار رایج است.
برای برخی افراد، HL ممکن است هرگز به طور کامل از بین نرود. این افراد ممکن است تحت درمانهای منظم با شیمی درمانی، پرتو درمانی یا سایر روشهای درمانی قرار گیرند تا به کنترل آن تا زمانی که ممکن است و به تسکین علائم کمک کنند. یادگیری زندگی با HL که از بین نمیرود میتواند دشوار و بسیار استرس زا باشد.
از پزشک خود بخواهید که یک طرح مراقبت از بقا را ارائه دهد.
با پزشک خود در مورد تهیه یک برنامه مراقبت بقا برای خود صحبت کنید. این طرح ممکن است شامل موارد زیر باشد:
- برنامه پیشنهادی برای تستها و آزمونهای بعدی
- برنامه ای برای آزمایشهای دیگری که ممکن است در آینده به آنها نیاز داشته باشید، مانند آزمایشهای تشخیص زود هنگام (غربالگری) سایر انواع سرطان یا آزمایشهایی برای بررسی اثرات درازمدت سلامتی HL یا درمان آن.
- فهرستی از عوارض جانبی احتمالی دیر هنگام یا طولانی مدت درمان شما، از جمله مواردی که باید مراقب باشید و چه زمانی باید با پزشک خود تماس بگیرید.
- پیشنهادات رژیم غذایی و فعالیت بدنی
پیگیری بعد از لنفوم هوچکین
حتی اگر درمان را کامل کرده باشید، پزشکان شما همچنان میخواهند شما را از نزدیک تحت نظر داشته باشند. بسیار مهم است که به همه قرار ملاقاتهای بعدی خود بروید زیرا لنفوم هوچکین گاهی اوقات حتی چندین سال پس از درمان ممکن است عود کند.
برخی از عوارض جانبی درمان ممکن است برای مدت طولانی باقی بمانند یا حتی ممکن است تا سالها پس از اتمام درمان ظاهر نشوند. این ملاقاتها با پزشک زمان خوبی برای پرسیدن سؤالات و صحبت در مورد هرگونه تغییر یا مشکلی است که متوجه آنها میشوید یا نگرانیهایی که دارید.
بسیاری از افراد مبتلا به لنفوم هوچکین درمان میشوند اما درمانهای مورد استفاده میتواند منجر به مشکلات سلامتی در آینده شود. به طور منظم به پزشک خود مراجعه کنید، آزمایشهای غربالگری سرطان توصیه شده را انجام دهید و هر تغییری را که در احساس خود مشاهده میکنید به تیم مراقبتهای بهداشتی خود بگویید.
آزمایشها و تستها
در طول ویزیتهای بعدی، پزشک در مورد علائم سؤال میکند، معاینات فیزیکی انجام میدهد و ممکن است آزمایشهای خون یا آزمایشهای تصویر برداری مانند PET یا سی تی اسکن را انجام دهد. ویزیت پزشک معمولاً هر 3 تا 6 ماه برای چندین سال اول پس از درمان توصیه میشود. با گذشت زمان، فاصله زمانی بین ویزیتها را میتوان افزایش داد اما حتی پس از 5 سال شما باید حداقل سالی یک بار به انکولوژیست خود مراجعه کنید.
افرادی که لنفوم هوچکین آنها با درمان از بین نمیرود، یک برنامه پیگیری خواهند داشت که بر اساس وضعیت خاص آنها است.
نگهداری از بیمه درمانی و کپی از سوابق پزشکی شما
حتی پس از درمان، حفظ بیمه درمانی بسیار مهم است. آزمایشها و ویزیتهای پزشک هزینه زیادی دارد و حتی اگر کسی نمیخواهد به بازگشت سرطان خود فکر کند، ممکن است این اتفاق بیفتد.
در برخی مواقع پس از درمان، ممکن است به پزشک جدیدی مراجعه کنید که سابقه پزشکی شما را نمیداند. مهم است که کپیهایی از سوابق پزشکی خود را نگه دارید تا به پزشک جدید خود جزئیات تشخیص و درمان خود را ارائه دهید. در نگهداری کپی از سوابق پزشکی مهم اطلاعات بیشتری بیاموزید.
آیا میتوانم خطر پیشرفت یا بازگشت لنفوم هوچکین را کاهش دهم؟
اگر لنفوم هوچکین دارید (یا داشته اید)، احتمالاً میخواهید بدانید که آیا کارهایی وجود دارد که میتوانید انجام دهید که ممکن است خطر عود لنفوم را کاهش دهد، مانند ورزش کردن، خوردن نوع خاصی از رژیم غذایی یا مصرف مکملهای غذایی. متأسفانه، هنوز مشخص نیست که آیا کارهایی وجود دارد که میتوانید انجام دهید که به شما کمک کند.
اتخاذ رفتارهای سالم مانند سیگار نکشیدن، خوب غذا خوردن، فعالیت بدنی منظم و حفظ وزن مناسب ممکن است کمک کند اما هیچ کس به طور قطع نمیداند. با این حال، ما میدانیم که این نوع تغییرات میتواند اثرات مثبتی بر سلامت شما داشته باشد که میتواند فراتر از خطر ابتلا به HL یا سایر سرطانها باشد.
درباره مکملهای غذایی
تاکنون نشان داده نشده است که یک مکمل غذایی (از جمله ویتامینها، مواد معدنی و محصولات گیاهی) به وضوح به کاهش خطر پیشرفت یا بازگشت لنفوم هوچکین کمک کند. این بدان معنا نیست که هیچ مکملی کمکی نخواهد کرد اما مهم است که بدانید هیچ کدام این کار را ثابت نکرده اند.
مکملهای غذایی مانند داروها در ایالات متحده تنظیم نمیشوند – لازم نیست قبل از فروش، اثر بخشی (یا حتی ایمن بودن) آنها ثابت شود، اگرچه محدودیتهایی در مورد آن چه مجاز به انجام آن هستند، وجود دارد. اگر به مصرف هر نوع مکمل غذایی فکر میکنید، با تیم مراقبتهای بهداشتی خود صحبت کنید. آنها میتوانند به شما کمک کنند تصمیم بگیرید که کدام یک را میتوانید با خیال راحت استفاده کنید و در عین حال از مواردی که ممکن است مضر باشند اجتناب کنید.
اگر لنفوم هوچکین عود کند
اگر لنفوم هوچکین عود کند (recurs یا باز گردد)، گزینههای درمانی شما به محل لنفوم، درمانهایی که قبلاً انجام داده اید، مدت زمانی که از درمان گذشته است و سلامت فعلی و ترجیحات فعلی شما بستگی دارد. برای اطلاعات بیشتر در مورد نحوه درمان مکرر لنفوم هوچکین، به مبحث درمان لنفوم هوچکین کلاسیک بر اساس مرحله مراجعه کنید.
آیا میتوانم بعد از درمان به سرطان دوم مبتلا شوم؟
افرادی که لنفوم هوچکین داشته اند هنوز هم میتوانند سرطانهای دیگر را بگیرند. در واقع، بازماندگان لنفوم هوچکین در معرض خطر بیشتری برای ابتلا به برخی دیگر از انواع سرطان هستند. در مبحث دومین سرطان بعد از لنفوم هوچکین اطلاعات بیشتری را بدست آورید.
دریافت حمایت عاطفی
زمانی که لنفوم بخشی از زندگی شما باشد، مقداری احساس افسردگی، اضطراب یا نگرانی طبیعی است. برخی افراد بیش از دیگران تحت تأثیر قرار میگیرند اما همه میتوانند از کمک و حمایت افراد دیگر بهره مند شوند، خواه دوستان و خانواده، گروههای مذهبی، گروههای حمایتی، مشاوران حرفه ای یا دیگران.
عوارض جانبی دیر هنگام و طولانی مدت درمان لنفوم هوچکین
هر نوع درمان برای لنفوم هوچکین (HL) دارای عوارض جانبی است که میتواند ماهها یا بیشتر طول بکشد و برخی از آنها ممکن است تا مدتها پس از پایان درمان ظاهر نشوند. برخی از عوارض جانبی، مانند از دست دادن باروری (توانایی بچه دار شدن)، آسیب قلبی و هورمونهای تیروئید پایین، میتوانند دائمی باشند.
از آن جایی که بسیاری از افراد در حال حاضر برای مدت طولانی پس از درمان خود زندگی میکنند، مراقبت از این عوارض جانبی دیر هنگام و طولانی مدت بسیار مهم است. حتماً با تیم درمانی خود در مورد این که این اثرات احتمالی صحبت کنید تا بدانید چه مواردی را باید رعایت کنید و به پزشک گزارش دهید.
سرطانهای دوم
یکی از عوارض جانبی غیر معمول اما بسیار جدی درمان HL، ایجاد نوع دوم سرطان در آینده است. افرادی که لنفوم هوچکین داشته اند در معرض خطر بیشتری برای بسیاری از انواع سرطان هستند.
مسائل باروری
یک اثر طولانی مدت احتمالی شیمی درمانی و پرتو درمانی، به ویژه در بیماران جوان تر، کاهش یا از دست دادن باروری است. به عنوان مثال، برخی از داروهای شیمی درمانی میتوانند بر توانایی مرد در ساختن اسپرم تأثیر بگذارند که ممکن است کوتاه مدت یا دائمی باشد. اگر بیمار به اندازه کافی بزرگ است و قرار است داروهای شیمی درمانی دریافت کند که میتواند بر باروری تأثیر بگذارد، بانک اسپرم باید قبل از شروع شیمی درمانی در نظر گرفته شود.
به همین ترتیب، در زنان ممکن است با شیمی درمانی قاعدگی متوقف شود. این وضعیت ممکن است به حالت عادی بازگردد. برخی از زنان پس از درمان یائسه میشوند. تابش اشعه به قسمت تحتانی شکم (belly) میتواند باعث ناباروری شود، مگر اینکه تخمدانها با جراحی به خارج از میدان تابش منتقل شوند. حرکت تخمدانها بر میزان بهبودی تأثیری ندارد زیرا HL تقریباً هرگز به تخمدانها سرایت نمیکند.
عفونتها
به دلایل ناشناخته، سیستم ایمنی افراد مبتلا به لنفوم هوچکین اغلب آن طور که باید کار نمیکند. درمانهایی مانند شیمی درمانی، پرتو درمانی یا برداشتن طحال (splenectomy) میتواند به این مشکل بیفزاید. (زمانی معمولاً برداشتن طحال انجام میشد اما اکنون به ندرت مورد نیاز است.) بیمارانی که طحال آنها برداشته میشود باید علیه باکتریهای خاصی واکسینه شوند.
همه افرادی که لنفوم هوچکین داشته اند باید واکسن آنفولانزای خود را دنبال کنند. دریافت واکسن و درمان سریع عفونتها بسیار مهم است.
مشکلات تیروئید
تابش به قفسه سینه یا گردن برای درمان لنفوم هوچکین میتواند غده تیروئید را تحت تاثیر قرار دهد و باعث شود هورمون تیروئید کمتری تولید کند. افراد مبتلا به این بیماری که به عنوان کم کاری تیروئید شناخته میشود، ممکن است نیاز داشته باشند تا پایان عمر خود هر روز داروی تیروئید مصرف کنند. هر فردی که تحت پرتو درمانی به گردن یا بالای قفسه سینه است باید حداقل سالی یک بار عملکرد تیروئید خود را با آزمایش خون بررسی کند.
بیماری قلبی و سکته مغزی
افرادی که به قفسه سینه تابش اشعه داشته اند، بیشتر در معرض خطر بیماری قلبی و حملات قلبی هستند. اگرچه این مشکل با تکنیکهای پرتو درمانیهای مدرنتر کمتر شده است. برخی از داروهای شیمی درمانی مانند دوکسوروبیسین (Adriamycin) نیز میتوانند باعث آسیب قلبی شوند. گاهی اوقات آسیب تا بیش از 10 سال پس از درمان دیده نمیشود. پزشک ممکن است بخواهد عملکرد قلب شما را برای سالها پس از درمان بررسی کند.
تابش به گردن احتمال سکته مغزی را افزایش میدهد زیرا میتواند به عروق خونی گردن که خون مغز را تامین میکنند، آسیب برساند. ممکن است از سونوگرافی برای بررسی سلامت رگهای خونی گردن استفاده شود.
سیگار کشیدن، کلسترول بالا و فشار خون بالا (hypertension) نیز خطر بیماری قلبی و سکته را افزایش میدهد. مهم است که آن چه میتوانید برای کمک به کاهش خطر انجام دهید، مانند این که سیگار نکشید، وزن مناسبی داشته باشید، فعال باشید و رژیم غذایی سالم داشته باشید. همچنین مهم است که معاینات منظم با پزشک خود داشته باشید و در صورت داشتن فشار خون بالا تحت درمان قرار بگیرید.
آسیب ریه
داروی شیمی درمانی بلئومایسین میتواند به ریهها آسیب برساند، همان طور که پرتو درمانی به قفسه سینه نیز آسیب میرساند. این میتواند منجر به مشکلاتی مانند تنگی نفس شود که ممکن است تا سالها پس از درمان ظاهر نشود. سیگار کشیدن همچنین میتواند به ریهها آسیب جدی وارد کند، بنابراین مهم است که افرادی که این درمانها را انجام داده اند سیگار نکشند.
نگرانیهای ویژه در بازماندگان لنفوم هوچکین دوران کودکی
همان طور که درمان لنفوم هوچکین دوران کودکی نیازمند یک رویکرد بسیار تخصصی در کودکان است، پیگیری و نظارت بر عود (عود HL) و اثرات دیر هنگام درمان نیز نیاز دارد. پیگیری دقیق بعد از درمان بسیار مهم است و باید تا آخر عمر کودک انجام شود. هر چه مشکلات زودتر پیدا شوند، احتمال بیشتری وجود دارد که بتوان آنها را به طور موثر درمان کرد.
همراه با عوارض جانبی فیزیکی (از جمله موارد ذکر شده در بالا)، بازماندگان لنفوم دوران کودکی ممکن است مشکلات عاطفی یا روانی داشته باشند. آنها همچنین ممکن است مشکلاتی در عملکرد عادی و کار در مدرسه داشته باشند. این موارد اغلب با حمایت و تشویق قابل حل است. پزشکان و سایر اعضای تیم مراقبتهای بهداشتی نیز اغلب میتوانند برنامهها و خدمات حمایتی ویژه ای را برای کمک به کودکان پس از درمان توصیه کنند.
برای کمک به افزایش آگاهی از اثرات دیررس و بهبود مراقبتهای بعدی برای بازماندگان سرطان دوران کودکی در طول زندگی، گروه انکولوژی کودکان (COG) دستورالعملهای پیگیری طولانی مدت را برای بازماندگان سرطان دوران کودکی ایجاد کرده است. این دستورالعملها میتوانند به شما کمک کنند تا بدانید چه مواردی را باید رعایت کنید، چه نوع غربالگری سلامتی باید انجام شود و چگونه ممکن است عوارض دیر هنگام درمان شود.
بسیار مهم است که در مورد مشکلات احتمالی دراز مدت با تیم مراقبت بهداشتی فرزندتان صحبت کنید و مطمئن شوید که برنامه ای برای مراقبت از این مشکلات و درمان آنها در صورت نیاز وجود دارد. برای کسب اطلاعات بیشتر، از پزشکان فرزند خود در مورد دستورالعملهای نجات COG سوال کنید. دستورالعملها برای متخصصان مراقبتهای بهداشتی نوشته شده است. نسخههای بیمار برخی از دستورالعملها (بهعنوان پیوندهای سلامت) نیز موجود است اما از شما میخواهیم آنها را با یک پزشک در میان بگذارید.
دومین سرطان بعد از لنفوم هوچکین
بازماندگان سرطان ممکن است تحت تأثیر تعدادی از مشکلات سلامتی قرار گیرند اما اغلب نگرانی اصلی مواجهه مجدد با سرطان است. اگر همان نوع سرطان پس از درمان باز گشته و عود کند، عود (recurrence) نامیده میشود اما برخی از بازماندگان سرطان ممکن است بعداً (معمولاً بیش از 10 سال پس از درمان) به نوع دیگری از سرطان مبتلا شوند. این سرطان دوم نامیده میشود.
افرادی که لنفوم هوچکین (HL) داشته اند میتوانند به هر نوع سرطان دوم مبتلا شوند اما تحقیقات نشان داده است که خطر ابتلا به برخی سرطانها در آنها افزایش مییابد. اینها معمولاً با درمانهای مورد استفاده برای لنفوم هوچکین مرتبط هستند. شیمی درمانی با سرطان خون و پرتو درمانی با سرطان اندامهای ناحیه تحت درمان مرتبط است. سرطانها عبارتند از:
- سرطان خون
- سندرم میلودیسپلاستیک (Myelodysplastic syndrome یا MDS)
- لنفوم غیر هوچکین
- سرطان سینه (در زنان)
- سرطان ریه
- سرطان تیروئید
- سرطان لب و زبان
- سرطان غدد بزاقی
- سرطان معده
- سرطان روده بزرگ
- سرطان کبد
- سرطان پانکراس
- سرطان استخوان
- سرطان بافت نرم
- سرطان مقعد
- سرطان رحم
- سرطان حالب (لوله ای که کلیه و مثانه را به هم متصل میکند)
- ملانوم پوست
- سارکوم کاپوزی (Kaposi sarcoma)
افزایش خطر ابتلا به بسیاری از این سرطانها با درمان با پرتو درمانی مرتبط است. مثلا:
- زنانی که تابش قفسه سینه داشته اند (به ویژه قبل از 30 سالگی) در معرض خطر بیشتری برای ابتلا به سرطان سینه هستند.
- تابش به گردن با خطر بالاتر سرطان تیروئید مرتبط است.
- تابش به قفسه سینه با خطر بالاتر سرطان ریه مرتبط است.
اما با گذشت زمان، استفاده از پرتو برای درمان لنفوم هوچکین بسیار تغییر کرده است. پرتو درمانی در حال حاضر با دوزهای کمتر و اغلب فقط به نواحی تحت تأثیر مستقیم لنفوم داده میشود. خطرات با پرتو درمانی مدرن به احتمال زیاد کمتر است، هنوز مطالعات طولانی مدت برای اطمینان لازم است.
شیمی درمانی (chemo)، به ویژه با داروهایی به نام عوامل آلکیله کننده (مانند داکاربازین و سیکلوفسفامید) با خطر بالاتر ابتلا به چندین نوع سرطان، از جمله سرطان خون، مرتبط است. امروزه، از عوامل آلکیله کننده در موارد کمتر و با دوزهای بسیار کمتر استفاده میشود، بنابراین این خطرات احتمالاً به اندازه گذشته بالا نیستند اما مجدداً، برای اطمینان به مطالعات طولانی مدت نیاز است.
مراقبتهای بعدی پس از درمان لنفوم هوچکین
پس از تکمیل درمان برای HL، شما همچنان باید به طور منظم به پزشک خود مراجعه کنید و ممکن است آزمایشاتی برای جستجوی علائم بازگشت سرطان انجام دهید. در مورد علائم یا مشکلات جدید به آنها اطلاع دهید زیرا ممکن است ناشی از بازگشت لنفوم، بیماری جدید یا سرطان دوم باشد.
زنانی که قبل از 30 سالگی تحت پرتو درمانی قفسه سینه (مانند پرتو درمانی میدان منتل) قرار گرفتند، خطر ابتلا به سرطان سینه را افزایش میدهند. انجمن سرطان آمریکا غربالگری سالانه سرطان سینه را با ام آر آی سینه همراه با ماموگرافی و معاینات بالینی پستان از سن 30 سالگی برای این زنان توصیه میکند. برخی از متخصصان توصیه میکنند که غربالگری 8 تا 10 سال پس از درمان یا در سن 40 سالگی (هر کدام زودتر باشد) شروع شود.
گروه انکولوژی کودکان دستورالعملهایی برای پیگیری بیماران تحت درمان سرطان در دوران کودکی، نوجوانی یا بزرگسالی دارد، از جمله غربالگری برای سرطان دوم.
بازماندگان لنفوم هوچکین همچنین باید دستورالعملهای انجمن سرطان آمریکا را برای تشخیص زود هنگام سرطان، مانند سرطان روده بزرگ و ریه، دنبال کنند. اکثر متخصصان هیچ آزمایش دیگری را برای جستجوی سرطان دوم توصیه نمیکنند مگر اینکه علائمی داشته باشید.
آیا میتوانم خطر ابتلا به سرطان دوم را کاهش دهم؟
اقداماتی وجود دارد که میتوانید برای کمک به کاهش خطر و سالم ماندن تا حد امکان انجام دهید. به عنوان مثال، دوری از محصولات دارای تنباکو مهم است. سیگار خطر ابتلا به بسیاری از سرطانها را افزایش میدهد، از جمله برخی از سرطانهای دوم که در افرادی که لنفوم هوچکین داشته اند، دیده میشوند.
برای کمک به حفظ سلامتی، بازماندگان لنفوم هوچکین باید موارد زیر را رعایت کنند:
- به وزن سالم برسید و در آن بمانید.
- فعالیت بدنی خود را حفظ کنید و زمان نشستن یا دراز کشیدن را محدود کنید.
- از یک الگوی تغذیه سالم پیروی کنید که شامل مقدار زیادی میوه، سبزیجات و غلات کامل باشد و از مصرف گوشت قرمز و فرآوری شده، نوشیدنیهای شیرین و غذاهای بسیار فرآوری شده محدود یا اجتناب شود.
- الکل ننوشید. اگر مشروب میخورید، بیش از 1 نوشیدنی در روز برای زنان یا 2 نوشیدنی در روز برای مردان مصرف نکنید.
این مراحل همچنین ممکن است خطر سایر مشکلات سلامتی از جمله بیماری قلبی را کاهش دهد.
چه چیزی در تحقیقات لنفوم هوچکین جدید است؟
درمانهایی که امروزه مورد استفاده قرار میگیرند حدود 8 مورد از 10 مورد لنفوم هوچکین (HL) را درمان میکنند. هنوز تحقیقات مهمی در بسیاری از بیمارستانهای دانشگاهی، مراکز پزشکی و سایر موسسات در سراسر جهان در حال انجام است. دانشمندان در حال نزدیک شدن به یافتن علت این بیماری و نحوه درمان بهتر آن هستند. این امر برای مواردی که به سختی قابل درمان هستند، مانند مواردی که به درمانهای فعلی پاسخ نمیدهند یا پس از درمان برمیگردند، بسیار جالب است.
پزشکان همچنین به دنبال راههایی برای محدود کردن عوارض جانبی طولانی مدت مرتبط با درمان لنفوم هوچکین هستند.
تستهای تصویر برداری
اسکن PET/CT معمولاً برای کمک به پزشکان در مرحله لنفوم هوچکین و تصمیم گیری در مورد میزان درمان مورد نیاز استفاده میشود. پزشکان همچنین در حال بررسی این موضوع هستند که آیا اسکن PET/CT انجام شده در طول درمان میتواند به تصمیم گیری در مورد نیاز به درمان بیشتر یا کمتر کمک کند.
محققان در تلاشند تا دریابند که آیا اسکن MRI ممکن است در کودکان و نوجوانان مبتلا به HL نیز موثر باشد. اگر چنین باشد، به معنای قرار گرفتن در معرض اشعه کمتر و عوارض جانبی طولانی مدت در جوانان است.
درمان
نرخ بهبودی کلی برای HL بالا است اما عوارض جانبی طولانی مدت درمان موضوع مهمی است. یک حوزه بسیار فعال از تحقیقات به سمت فهم این است که کدام بیماران را میتوان با درمان ملایم تر درمان کرد و کدام بیماران به درمان قوی تری نیاز دارند.
تابش – تشعشع
پزشکان به دنبال این هستند که ببینند کدام بیماران (به ویژه کودکان) ممکن است با دوزهای کمتر پرتو یا حتی بدون تشعشع به همان خوبی عمل کنند. آنها همچنین در حال بررسی هستند که آیا اشکال جدیدتر پرتو درمانی، مانند پرتو درمانی تعدیل شده با شدت (intensity-modulated radiation therapy یا IMRT) و پروتون درمانی (proton therapy)، ممکن است برای لنفوم هوچکین مفید باشد یا خیر. این رویکردها تشعشع را با دقت بیشتری روی تومورها متمرکز میکنند که دوز رسیدن به بافتهای طبیعی مجاور را محدود میکند.
شیمی درمانی
یکی از حوزههای تحقیقاتی مرتبط، یافتن درمانهای کمتر سمی است که عوارض جانبی طولانی مدت کمتری دارند اما همچنان تا حد امکان بیماران را درمان میکنند. دوزهای پایین تر شیمی درمانی (chemo) و همچنین داروهای شیمی درمانی جدید و ترکیبات دارویی در حال مطالعه هستند. بسیاری از این داروها در حال حاضر برای درمان سرطانهای دیگر استفاده میشوند و در برابر HL که پس از سایر درمانهای شیمی درمانی عود کرده است، نوید بخش هستند. مطالعات در حال انجام است تا ببینند آیا این داروها میتوانند بهتر از داروهایی که اکنون استفاده میشوند، کار کنند.
پزشکان همچنین به دنبال داروهای شیمی درمانی بهتری برای استفاده در پیوند سلولهای بنیادی هستند. باز هم، بهبود نتایج در عین محدود کردن عوارض جانبی طولانی مدت هدف است.
روش دیگر استفاده از داروهای جدیدتر است که سلولهای HL را بهتر مورد هدف قرار میدهند. برخی از این موارد در زیر توضیح داده شده است.
درمان هدفمند (Targeted therapy)
داروهای جدیدتری که متفاوت از داروهای شیمی درمانی استاندارد عمل میکنند اکنون در حال مطالعه هستند. محققان در مورد تغییرات ژنی موجود در سلولهای HL چیزهای زیادی یاد میگیرند. این میتواند منجر به تولید داروهایی شود که این تغییرات را هدف قرار میدهند و سلولهای طبیعی را حفظ میکنند. اینها به عنوان داروهای درمان هدفمند (targeted therapy drugs) شناخته میشوند. بسیاری از انواع دیگر سرطان در حال حاضر با درمانهای هدفمند درمان میشوند.
برخی از این داروهای هدفمند به صورت ترکیبی مورد مطالعه قرار میگیرند، به این امید که در صورت مصرف با هم بهتر عمل کنند. بسیاری از آنها همراه با سایر درمانهای سرطان مانند شیمی درمانی ویا پرتو درمانی تجویز میشوند.
ایمونوتراپی (شامل آنتی بادیهای مونوکلونال)
ایمونوتراپی درمانی است که به سیستم ایمنی بدن کمک میکند تا سلولهای سرطانی را پیدا کرده و به آنها حمله کند. ایمونوتراپی در برابر چندین نوع سرطان از جمله لنفوم هوچکین مفید است.
مهار کنندههای ایست بازرسی ایمنی
سلولهای سیستم ایمنی به طور معمول دارای موادی بر روی خود هستند که به عنوان نقاط بازرسی برای جلوگیری از حمله به سلولهای سالم بدن عمل میکنند. سلولهای سرطانی گاهی اوقات از این نقاط بازرسی برای جلوگیری از حمله سیستم ایمنی استفاده میکنند. امروزه داروهایی که این نقاط بازرسی را مسدود میکنند برای درمان HL پس از آزمایش سایر درمانها استفاده میشود.
اکنون محققان در حال بررسی روشهای دیگر استفاده از این داروها هستند. به عنوان مثال، آنها به دنبال این هستند که آیا این داروها ممکن است به عنوان “درمان نگهدارنده یا maintenance therapy” برای جلوگیری از بازگشت HL پس از پیوند مورد استفاده قرار گیرند. محققان همچنین آنها را به عنوان اولین درمان برای لنفوم هوچکین آزمایش میکنند.
استفاده از مهار کنندههای ایست بازرسی ایمنی در کودکان و نوجوانان و همچنین در افراد مسن که برای دریافت درمان استاندارد بسیار بیمار هستند نیز در حال مطالعه است. چندین داروی دیگر بازدارنده پست بازرسی نیز در حال مطالعه هستند.
درمان با سلول T با گیرنده آنتی ژن کایمریک (Chimeric antigen receptor یا CAR)
در این درمان، سلولهای ایمنی به نام سلولهای T از خون بیمار برداشته شده و در آزمایشگاه تغییر داده میشوند تا گیرندههایی به نام گیرندههای آنتی ژن کایمریک یا CAR روی سطح خود داشته باشند. این گیرندهها میتوانند به پروتئینهای سطح سلولهای لنفوم متصل شوند. سلولهای T تغییر یافته سپس در آزمایشگاه تکثیر میشوند و دوباره در خون بیمار قرار میگیرند. سپس میتوانند سلولهای لنفوم را پیدا کرده و یک حمله ایمنی دقیق علیه آنها انجام دهند.
این تکنیک نتایج دلگرم کننده ای را در آزمایشات بالینی اولیه علیه برخی از لنفومهای هوچکین که به سختی قابل درمان هستند، نشان داده است. پزشکان هنوز در حال بهبود نحوه ساخت سلولهای T و در حال یادگیری بهترین راههای استفاده از آنها هستند. درمان با سلول T CAR در حال حاضر فقط در آزمایشات بالینی در دسترس است.
آنتی بادیهای مونوکلونال
آنتی بادیهای مونوکلونال (mAbs) نسخههای ساخته شده توسط انسان از پروتئینهای سیستم ایمنی هستند. برخی میتوانند سلولهای سرطانی را به تنهایی از بین ببرند. برخی دیگر مولکولهای رادیواکتیو یا سموم سلولی به آنها متصل هستند که به کشتن سلولهای سرطانی کمک میکنند. مزیت این داروها این است که به نظر میرسد سلولهای لنفوم را هدف قرار میدهند در حالی که عوارض جانبی کمتری نسبت به داروهای شیمی درمانی استاندارد دارند. آنها ممکن است به تنهایی یا همراه با شیمی درمانی استفاده شوند.
برخی از mAbs، مانند brentuximab vedotin (Adcetris) و rituximab (Rituxan)، در حال حاضر برای درمان برخی موارد HL استفاده میشوند. اکنون محققان در حال بررسی هستند که آیا این داروها ممکن است از راههای دیگر مفید باشند یا خیر.
به عنوان مثال، برنتوکسیماب اکنون در حال بررسی است تا ببینیم آیا ممکن است در مراحل اولیه بیماری یا به عنوان بخشی از درمان مورد استفاده برای آماده شدن برای پیوند مفید باشد. اکنون مطالعاتی در حال انجام است تا ببینیم آیا ریتوکسیماب میتواند به درمان اشکال کلاسیک HL و همچنین نوع غالب لنفوسیت گرهدار کمک کند. محققان همچنین به دنبال بهترین راه برای استفاده از mAbs در کنار درمان استاندارد هستند. بسیاری از mAbهای جدیدتر نیز اکنون در حال مطالعه هستند.
مطالب مرتبط با لنفوم هوچکین:
- مروری بر ویروس های انکوژنیک
- سرطان دهانه رحم (Cervical Cancer) چیست؟
- تومورهای کارسینوئید ریه چیست؟ انواع، علائم و درمان
- سرطان غدد بزاقی (Salivary Gland Cancer) چیست؟
- سرطان تیروئید (Thyroid Cancer) چیست؟ علائم، تشخیص و درمان
- سندرمهای میلودیسپلاستیک (Myelodysplastic Syndromes) چیست؟ علائم، تشخیص و درمان
- نرخ رسوب گلبول قرمز (آزمایش ESR)
- سیستم لنفاوی: اندامها، عملکردها، بیماریها
مترجم: فاطمه فریادرس




فرق لنفوم هوچگین با غیر هوچگین چیست
هوچکین: وجود سلول Reed-Sternberg، انتشار منظمتر، معمولاً درمانپذیرتر.
غیرهوچکین: انواع بسیار متنوع، انتشار نامنظمتر، رفتار و درمان متغیر.